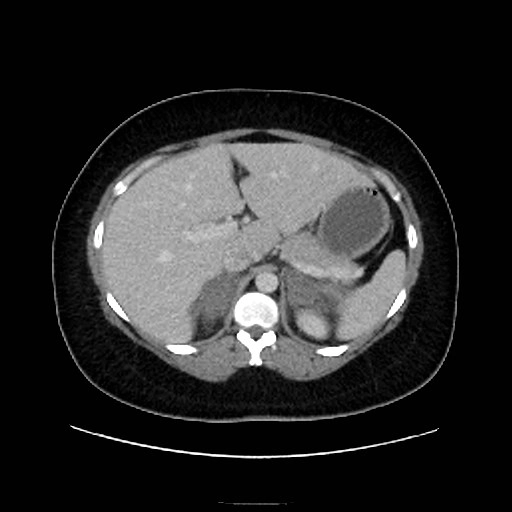
Huyết khối tĩnh mạch thượng thận (Adrenal vein thrombosis)

Danh sách danh tài liệu
- Danh sách danh mục
-
Sản khoa
-
Thai quý I
-
VI. Thai ngoài tử cung
- Thai ngoài tử cung đoạn vòi (Tubal ectopic pregnancy)
- Thai ngoài tử cung đoạn kẽ (Interstitial ectopic pregnancy)
- Thai bám sẹo mổ lấy thai (Cesarean section scar pregnancy)
- Thai ở cổ tử cung (Cervical pregnancy)
- Thai ngoài tử cung ở buồng trứng (Ovarian ectopic pregnancy)
- Song thai hỗn hợp (Heterotopic pregnancy)
- Thai ngoài tử cung trong ổ bụng
-
VII. Hệ thần kinh trung ương thai nhi
- Giải phẫu bình thường hệ thần kinh trung ương thai quý I (Normal CNS anatomy in first trimester)
- Thai vô sọ (Acrania, Exencephaly và Anencephaly)
- Thoát vị não-màng não (Encephalocele)
- Não thất duy nhất (Holoprosencephaly-HPE)
- Dãn não thất (Ventriculomegaly)
- Tật chẻ đôi đốt sống thể hở (Open spina bifida)
- Bất thường hố sau quý I
-
VIII. Mặt và cổ thai quý I
- Giải phẫu và mặt cắt siêu âm mặt thai quý I
- Bất thường mặt trong các dị tật thần kinh và lệch bội
- Bất sản, thiểu sản xương mũi
- Giải phẫu siêu âm xương hàm trên
- Sứt môi hở hàm ếch (Cleft lip and palate)
- Cằm nhỏ (Micrognathia)
- Nang bạch huyết vùng cổ quý I (Cystic hygroma)
- Đo độ mờ da gáy (Nuchal translucency)
-
X. Tiêu hóa thai nhi
- Giải phẫu siêu âm đường tiêu hóa thai quý I
- Thoát vị rốn thai quý I (Omphalocele)
- Hở thành bụng thai quý I (Gastroschisis)
- Ngũ chứng Cantrell thai quý I
- Bất thường phức hợp cơ thể (Body stalk anomaly)
- Lộn ổ nhớp và hội chứng OEIS thai quý I
- Ruột tăng âm thai quý I (Echogenic bowel)
- Nang trong ổ bụng thai quý I
- Giải phẫu siêu âm mạch máu bụng thai quý I
- Bất thường mạch máu trong ổ bụng
-
XI. Hệ tiết niệu thai nhi
- Giải phẫu siêu âm tiết niệu thai quý I
- Bàng quang to (Megacystis) và tắc nghẽn đường tiết niệu dưới (Lower urinary tract obstruction)
- Giãn đường tiết niệu thai quý I
- Bất sản thận hai bên thai quý I (Bilateral renal agenesis)
- Bất sản thận một bên thai quý I (Unilateral renal agenesis)
- Lộn bàng quang (Bladder exstrophy)
-
Thần kinh thai nhi
-
Bất thường đường giữa
- Bất sản thể chai hoàn toàn (Complete ACC)
- Bất sản một phần thể chai và thiểu sản thể chai (Partial agenesis & hypoplasia of the corpus callosum)
- Nang khe liên bán cầu/ hội chứng AVID (Interhemispheric cyst & AVID syndrome)
- Não trước không phân chia thể không phân chia (Alobar holoprosencephaly)
- Não trước không phân chia thể bán phần thùy (Semilobar holoprosencephaly)
- Não trước không phân chia thể phân thùy (Lobar holoprosencephaly)
- Loạn sản vách-thị thai nhi (Septo-optic dysplasia - SOD)
- Não trước không phân chia thể dính não giữa (Syntelencephaly)
-
Bất thường hố sau
- Dị dạng Chiari 2 thai nhi (Chiari 2 malformation)
- Dị dạng Chiari III ở thai nhi (Chiari III malformation)
- Dị dạng Dandy-Walker ở thai (Classic Dandy-Walker malformation)
- Thiểu sản thùy nhộng ở thai nhi (Vermian Hypoplasia)
- Nang túi Blake ở thai
- Giãn bể lớn hố sau ở thai nhi (Mega Cisterna Magna)
- Thiểu sản tiểu não ở thai nhi (Global Cerebellar Hypoplasia)
- Tật dính trám não thai nhi (Rhombencephalosynapsis)
-
Cột sống thai nhi
-
Cột sống thai
- Giải phẫu cột sống thai nhi
- Chẻ đôi đốt sống (Spina Bifida)
- Dị tật dính liền đầu- cổ (Iniencephaly)
- Thoái hóa cột sống bẩm sinh (Caudal Regression Sequence)
- Gù, vẹo cột sống (Kyphosis, Scoliosis)
- Hội chứng tủy sống bị cột chặt (Tethered Cord )
- Nứt dọc tủy sống (Diastematomyelia)
- U quái vùng cùng cụt (Sacrococcygeal Teratoma)
-
-
Ngực thai nhi
-
Bất thường ngực thai nhi
- Thoát vị hoành bẩm sinh thai nhi (Congenital Diaphragmatic Hernia)
- Bất thường nang tuyến phổi bẩm sinh thai nhi (Congenital Pulmonary Airway Malformation)
- Phổi biệt trí thai nhi (Bronchopulmonary sequestration)
- Nang phế quản thai nhi (Bronchogenic Cyst)
- Ứ khí thùy phổi bẩm sinh (Congenital lobar overinflation)
- Tắc nghẽn đường hô hấp trên bẩm sinh (Congenital High Airway Obstruction Sequence) (CHAOS)
- Bất sản phổi thai nhi (pulmonary agenesis)
- U, Dị dạng bạch huyết vùng nách thai nhi (Lymphangioma)
- U quái trung thất thai nhi (Mediastinal Teratoma)
- Tuyến ức bình thường thai nhi (Thymus)
-
-
Bụng thai nhi
-
Dị tật khuyết thành bụng
- Hở thành bụng thai nhi (Gastroschisis)
- Thoát vị rốn thai nhi (Omphalocele)
- Ngũ chứng Cantrell thai nhi (Pentalogy of Cantrell)
- Bất thường phức hợp cơ thể: Body stalk anomaly (BSA) / Limb body wall complex (LBWC)
- Lộn bàng quang thai nhi (Bladder Exstrophy - BE)
- Lộn ổ nhớp/ Hội chứng OEIS: Cloacal Exstrophy/OEIS Syndrome
-
Bất thường ống tiêu hóa
- Teo thực quản thai nhi (Esophageal Atresia- EA)
- Teo tá tràng thai nhi (Duodenal atresia)
- Teo hỗng- hồi tràng thai nhi (Jejunal, Ileal Atresia)
- Teo đại tràng thai nhi (Colonic Atresia)
- Tồn tại ổ nhớp (Cloacal Malformation)/ Xoang niệu sinh dục (Urogenital Sinus)
- Xoắn ruột thai nhi (Volvulus)
- Nang ruột đôi thai nhi (Enteric Duplication Cyst)
- Teo/tịt hậu môn thai nhi (Anal Atresia)
-
-
Hệ thống tiết niệu thai
-
Bất thường thận
- Bất sản thận hai bên thai nhi (Bilateral Renal Agenesis)
- Tắc khúc nối bể thận - niệu quản thai nhi (Ureteropelvic Junction Obstruction - UPJ Obstruction)
- Nang nước tiểu/ Tràn dịch quanh thận ở thai (Urinoma)
- Loạn sản thận do tắc nghẽn ở thai nhi (Obstructive Renal Dysplasia - ORD)
- Thận loạn sản đa nang thai nhi (Multicystic Dysplastic Kidney - MCDK)
- Thận đa nang di truyền lặn thai nhi (Autosomal Recessive Polycystic Kidney Disease - ARPKD)
- Thận đa nang di truyền trội thai (Autosomal Dominant Polycystic Kidney Disease - ADPKD)
- U trung mô thận thai nhi (Mesoblastic Nephroma)
-
Cơ xương khớp thai
-
Các loạn sản xương gây chết
- Loạn sản xương gây chết thai nhi (Thanatophoric Dysplasia - TD)
- Bất sản sụn/ thiểu sản sụn ở thai nhi (Achondrogenesis & Hypochondrogenesis)
- Tạo xương bất toàn tuýp II (gây chết) (Osteogenesis Imperfecta Type II - OI II)
- Hội chứng Đa ngón - Xương sườn ngắn (Short Rib-Polydactyly Syndromes - SRPS)
- Loạn sản xương cong thai nhi (Campomelic Dysplasia - CD)
- Loạn sản xương do cốt hóa không hoàn chỉnh (Atelosteogenesis)
- Bệnh giảm phosphatase kiềm ở thai nhi (Hypophosphatasia - HPP)
-
Dị tật chi (tay & chân)
- Cứng đa khớp bẩm sinh (Arthrogryposis Multiplex Congenita - AMC)/Chuỗi biến dạng do thai nhi bất động/giảm động (Fetal Akinesia/Hypokinesia Deformation Sequence - FA(H)DS)
- Bàn chân khoèo ở thai nhi (Clubfoot)
- Bàn chân gót lồi- Bàn chân ngựa gỗ (Rocker-Bottom Foot)
- Dị tật xương quay ở thai (Radial Ray Malformation)
- Ngón tay vẹo ở thai (Clinodactyly)
- Tật đa ngón thai (Polydactyly)
- Tật dính ngón ở thai (Syndactyly)
- Tật khuyết ngón (Ectrodactyly), tật chẻ bàn tay / bàn chân (Split Hand / Foot Malformation - SHFM) hay tật càng tôm
- Dị tật cụt chi thai (Amelia ) / Chi hải cẩu (Phocomelia)
- Loạn sản khu trú đầu trên xương đùi thai nhi (Proximal Focal Femoral Deficiency - PFFD)
- Thiếu hụt xương mác và xương chày thai (Fibular / Tibial Hemimelia)
- Hội Chứng Nàng tiên Cá (Sirenomelia)
-
Bánh nhau, màng ối, dây rốn
-
Bánh nhau
- Tổng quan bánh nhau và dây rốn (Approach to the Placenta and Umbilical Cord)
- Nhau bong non (Placental Abruption)
- Nhau tiền đạo (Placenta Previa) / Nhau bám thấp (Low-Lying Placenta)
- Nhau cài răng lược (Placenta Accreta Spectrum - PAS)
- Hồ huyết bánh nhau và huyết khối gai nhau (Placental Lakes & Intervillous Thrombus)
- Nhau phụ (Succenturiate Lobe)
- Nhau cuộn mép (Circumvallate Placenta)
- U máu bánh nhau (Chorioangioma)
- U quái bánh nhau (Placental Teratoma)
- Loạn Sản Trung Mô Bánh Nhau (Placental Mesenchymal Dysplasia - PMD)
- Bánh nhau dày (Placentomegaly)
- Nang bánh nhau (Placental Cysts)
-
Dây rốn
- Dây rốn bám mép / Dây rốn bám màng (Marginal Placental Cord Insertion / Velamentous Cord Insertion)
- Dây rốn một động mạch (Single Umbilical Artery - SUA)
- Giãn tĩnh mạch rốn thai nhi (Umbilical Vein Varix - UVV)
- Tồn Tại Tĩnh Mạch Rốn Phải thai nhi (Persistent Right Umbilical Vein - PRUV)
- Xoắn dây rốn (Umbilical Cord Coiling)
- Dây rốn thắt nút (True Umbilical Cord Knot)
- Mạch máu tiền đạo (Vasa Previa )
- Nang dây rốn (Umbilical Cord Cysts)
- Huyết khối mạch máu rốn (Umbilical Vessel Thrombosis)
-
-
Các hội chứng và rối loạn đa hệ thống
-
Phức hợp và phổ bệnh lý
- Phức hợp VACTERL (Phối hợp dị tật cột sống, hậu môn, tim, thận...)
- Hội Chứng CHARGE (Mắt, tim, mũi, sinh dục, tai)
- Hội Chứng Holt-Oram (Hội chứng Tim - Tay)
- Hội chứng Fryns (Thoát vị hoành, mặt thô, teo đầu chi).
- Hội Chứng PHACES ở thai (U máu mặt lớn và dị tật phối hợp)
- Bệnh Lý Thai Do Warfarin (tẹt mũi)
-
Đa thai
-
Nền tảng tiếp cận
- Bánh nhau- túi ối trong song thai (Chorionicity- Amnionicity)
- Song thai Hai nhau - Hai ối (Dichorionic Diamniotic Twins - DCDA)
- Song thai Một nhau - Hai ối (Monochorionic Diamniotic Twins - MCDA)
- Dán nhãn và Đánh giá tương hợp Song thai (Fetal Labeling & Concordance Assessment)
- Dây rốn quấn nhau ở song thai (Cord entanglement)
-
Biến chứng song thai một bánh nhau
- Hội chứng truyền máu song thai (Twin-Twin Transfusion Syndrome - TTTS)
- Thai chậm Tăng trưởng chọn lọc trong sinh đôi (Selective Fetal Growth Restriction - sFGR)
- Hội Chứng Thiếu Máu – Đa Hồng Cầu Song Thai (Twin Anemia-Polycythemia Sequence - TAPS)
- Hội Chứng Đảo ngược tưới máu Động mạch Song Thai một bánh nhau (Twin Reversed Arterial Perfusion - TRAPS):
-
-
Bệnh lý mẹ trong thai kỳ
-
Tử cung
- U xơ tử cung trong thai kỳ (Myoma in Pregnancy)
- Dị dạng tử cung trong thai kỳ (Müllerian Duct Anomalies in Pregnancy)
- Mất liên tục và Vỡ tử cung (Uterine Dehiscence/Rupture)
- Lạc nội mạc trong cơ tử cung (Adenomyosis) trong thai kỳ
- (Hở eo tử cung và Cổ tử cung ngắn) Cervical Insufficiency/Short Cervix
- Đánh giá khâu eo tử cung (Cervical Cerclage)
- Sót nhau (Retained Products of Conception - RPOC)
-
-
-
Siêu âm tim thai
-
III. Bệnh lý tim thai
-
Khiếm khuyết vách
- Thông liên nhĩ lỗ nguyên phát (ASD I) - Kênh nhĩ thất bán phần (Partial AVSD)
- Thông liên nhĩ xoang tĩnh mạch (ASD-sv)
- Thông liên nhĩ xoang vành (ASD-cs)
- Phình lỗ bầu dục- phình vách liên nhĩ (redundancy of the foramen ovale flap)
- Thông liên thất phần cơ (Muscular VSD)
- Thông liên thất phần màng (Perimembranous VSD)
- Thông liên thất phần nhận (Inlet VSD)
- Thông liên thất phần thoát (Outlet VSD)
- Kênh nhĩ thất toàn phần (complete AVSD)
- Kênh nhĩ thất không cân bằng (unbalanced AVSD)
-
Bất thường động mạch và ống động mạch
- Hẹp van động mạch phổi
- Tắc nghẽn van động mạch phổi với vách liên thất nguyên vẹn (PA-IVS)
- Hẹp van động mạch chủ nghiêm trọng
- Hẹp van động mạch chủ
- Teo van Động Mạch Phổi kèm Thông Liên Thất
- Không van động mạch phổi
- Hẹp eo động mạch chủ
- Gián đoạn cung động mạch chủ
- Cung động mạch chủ bên phải với ống động mạch bên phải
- RAA U-sign
- Cung động mạch chủ đôi
- Động mạch dưới đòn phải lạc chỗ
- Ống động mạch hình chữ S (S-Shaped DA), gấp khúc hoặc ngoằn ngoèo
- Co thắt ống động mạch
- Cửa sổ phế chủ
- Vòng động mạch phổi (Pulmonary arterial sling)
- Dò động mạch vành
- Dò động mạch phổi phải vào tâm nhĩ trái
-
Bất thường hệ thống tĩnh mạch
- Tồn tại tĩnh mạch rốn phải (PRUV)
- GIÃN TĨNH MẠCH RỐN (UVV)
- Shunt tĩnh mạch rốn- cửa- chủ (Bất sản ống tĩnh mạch DV)
- SHUNT CỬA-CHỦ (PORTOSYSTEMIC SHUNT)
- Tồn tại tĩnh mạch chủ trên trái (LSVC)
- Gián đoạn tĩnh mạch chủ dưới và tiếp nối với tĩnh mạch đơn (Azygos)
- Bất thường hồi lưu tĩnh mạch phổi toàn phần (TAPVC)
- Bất thường hồi lưu tĩnh mạch phổi bán phần (PAPVC)
-
-
Hệ tiêu hóa
-
Dạ dày
-
Khối u dạ dày
- Polyp dạ dày (Gastric Polyps)
- U mô đệm đường tiêu hóa (Gastrointestinal stromal tumor - GIST)
- Ung thư biểu mô tuyến dạ dày (Gastric adenocarcinoma)
- Di căn dạ dày và U lympho dạ dày (Gastric Metastases and Lymphoma)
- U mỡ dạ dày (Gastric lipoma)
- U cơ trơn dạ dày (Gastric leiomyoma)
- Linitis plastica
- Phân loại giai đoạn ung thư dạ dày (Gastric cancer (TNM staging))
-
Ruột non
-
Bệnh lý thoái hóa
- Khí trong thành ruột (Intramural bowel gas)
- Liệt ruột cơ năng (Adynamic ileus)
- Tắc ruột non (Small Bowel Obstruction - SBO)
- Lồng ruột (Intussusception)
- Tắc ruột do sỏi mật (Gallstone Ileus)
- Tắc ruột quai kín (Closed Loop Obstruction)
- Xoắn ruột non (Midgut volvulus)
- Bóng khí trong thành ruột (Pneumatosis cystoides intestinalis)
- Dính ruột (Abdominal adhesions)
- Thủng ruột non (Small bowel perforation)
-
Khối u ruột non
- U mỡ đường tiêu hóa (Gastrointestinal tract lipomas)
- U cơ trơn ruột non (Small bowel leiomyoma)
- U thần kinh nội tiết ruột non (Small bowel neuroendocrine tumor - SBNET)
- U mỡ van hồi manh tràng (Lipoma of ileocecal valve)
- Lắng đọng mỡ van hồi-manh tràng (Lipomatosis of the ileocecal valve)
- Hội chứng đa polyp Peutz-Jeghers (Peutz-Jeghers syndrome)
- Ung thư biểu mô tuyến ruột non (Adenocarcinoma of the small bowel)
- Lymphoma ruột non (Small bowel lymphoma)
-
Bệnh lý ruột thừa
- Sỏi ruột thừa (Appendicolith)
- Viêm ruột thừa cấp (Acute appendicitis)
- Viêm ruột thừa dưới gan (Subhepatic appendicitis)
- Áp xe ruột thừa (Appendicular abscess)
- Thủng ruột thừa (Perforated appendix)
- Đám quánh ruột thừa (Appendiceal phlegmon)
- Viêm mỏm ruột thừa (Stump appendicitis)
- U nhầy ruột thừa (Appendiceal mucocele)
- Lồng ruột thừa (Appendiceal intussusception)
- U tân sinh ruột thừa (Appendiceal neoplasms)
-
Đại tràng
-
Bệnh lý viêm nhiễm
- Viêm đại tràng do xạ trị (Radiation colitis)
- Viêm đại tràng nhiễm trùng (Infectious colitis)
- Viêm manh tràng giảm bạch cầu (Neutropenic Colitis [Typhlitis])
- Viêm loét đại tràng (Ulcerative Colitis)
- Phình đại tràng nhiễm độc (Toxic megacolon)
- Viêm đại tràng thiếu máu cục bộ (Ischemic colitis)
- Viêm ruột thừa (Appendicitis (summary))
- Viêm túi thừa đại tràng (Diverticulitis)
- Viêm bờm mỡ đại tràng (Epiploic appendagitis)
-
Bệnh lý thoái hóa
- Túi thừa đại tràng (Colonic diverticulosis)
- Xoắn đại tràng sigma (Sigmoid volvulus)
- Xoắn manh tràng (Cecal volvulus)
- Giả tắc đại tràng cấp/ Hội chứng Ogilvie (Colonic pseudo-obstruction)
- Tắc phân (Fecal impaction)
- Thủng đại tràng do ứ phân (Stercoral perforation)
- Viêm đại tràng do ứ phân (Stercoral colitis)
- Sa trực tràng (Rectal prolapse)
- Tắc đại tràng (Large Bowel Obstruction - LBO)
- Sỏi phân (Fecolith)
- Thủng đại tràng (Large bowel perforation)
-
Khối u đại tràng
- U nhầy ruột thừa (Appendiceal mucocele)
- Nang đuôi ruột (Tailgut cyst)
- Polyp đại tràng (Colon polyp)
- Hội chứng đa polyp tuyến gia đình (Familial Adenomatous Polyposis- FAP)
- Ung thư đại trực tràng (Colorectal Cancer - CRC)
- Polyp nhung mao đại trực tràng (Colorectal villous polyps)
- Ung thư trực tràng (Rectal cancer)
- U thần kinh nội tiết ruột thừa (Appendiceal neuroendocrine tumor)
- Lymphoma đại trực tràng (Large bowel lymphoma)
- Phân loại giai đoạn ung thư đại trực tràng (Colorectal cancer (staging))
- Phân loại giai đoạn ung thư trực tràng (Rectal cancer (staging))
-
-
Lách
-
Khối u ở lách
- Nang lách (Splenic Cyst)
- U máu lách (Splenic hemangioma)
- U mạch bạch huyết lách (Splenic lymphangioma)
- Lymphoma lách (Splenic lymphoma)
- Hamartoma lách (Splenic hamartoma)
- U mạch máu ác tính lách (Splenic angiosarcoma)
- Di căn lách (Splenic metastases)
- Tạo máu ngoài tủy tại lách (Extramedullary hematopoiesis in the spleen)
-
Gan
-
Bệnh lý viêm nhiễm
- Áp xe gan (Hepatic abscess)
- Lao gan lách (Hepatic and splenic tuberculosis)
- Bệnh nang sán gan (Hepatic hydatid infection)
- Áp xe gan do amip (Amoebic hepatic abscess)
- Bệnh sán máng (các biểu hiện ở gan) - Schistosomiasis (hepatic manifestations)
- Viêm gan cấp (Acute hepatitis)
- Viêm gan tự miễn (Autoimmune Hepatitis - AIH)
- Xơ gan mật nguyên phát (Primary Biliary Cholangitis - PBC)
-
Khối u ở gan
- Xơ gan hợp lưu (Confluent hepatic fibrosis)
- Nốt tái tạo gan (Regenerative liver nodule)
- Chẩn đoán phân biệt các nốt gan xơ (Cirrhotic liver nodules - differential)
- Nang quanh đường mật (Peribiliary cyst)
- Nang gan đơn giản (Simple hepatic cyst)
- U máu gan (Hepatic Hemangioma / Hepatic Venous Malformation)
- Tăng sản nốt khu trú (Focal Nodular Hyperplasia - FNH)
- Adenoma tế bào gan (Hepatocellular Adenoma - HCA)
- Đa u mô thừa đường mật/Hamartoma đường mật đa ổ (Multiple Biliary Hamartomas - MBH)
- U cơ mỡ mạch gan (Hepatic Angiomyolipoma - AML)
- Viêm giả u ở gan (Hepatic Inflammatory Pseudotumor - IPT)
- Ung thư biểu mô tế bào gan (Hepatocellular Carcinoma - HCC)
- Ung thư biểu mô tế bào gan dạng sợi (Fibrolamellar Hepatocellular Carcinoma - FL-HCC)
- U nội mô mạch máu dạng biểu mô ở gan (Epithelioid Hemangioendothelioma - EHE)
- U tuyến nang đường mật (Biliary Cystadenoma)
- Sarcoma mạch máu gan (Hepatic angiosarcoma)
- Di căn gan (Hepatic Metastases)
- Lymphoma gan (Hepatic Lymphoma)
- Ung thư đường mật trong gan (Intrahepatic Cholangiocarcinoma - ICC)
- Phân loại giai đoạn Ung thư gan (Hepatocellular Carcinoma staging)
-
Bệnh lý mạch máu
- Thay đổi đậm độ gan thoáng qua trên CT (Transient hepatic attenuation differences - THADs)
- Thay đổi tín hiệu gan thoáng qua trên MRI (Transient hepatic intensity difference - THIDs)
- Shunt động- tĩnh mạch cửa trong gan (Intrahepatic arterioportal shunt)
- Huyết khối tĩnh mạch cửa (Portal vein thrombosis - PVT)
- Tắc nghẽn gan thụ động (Passive hepatic congestion)
- Hội chứng Budd-Chiari (Budd-Chiari syndrome)
- Tăng áp lực tĩnh mạch cửa (Portal Hypertension)
- Nhồi máu gan (Hepatic infarction)
- Giãn mao mạch xoang gan (Hepatic peliosis)
- Giãn mạch xuất huyết di truyền (Hereditary Hemorrhagic Telangiectasia - HHT)
- Shunt cửa chủ trong gan qua tĩnh mạch cảnh (Transjugular intrahepatic portosystemic shunt - TIPS/TIPSS)
- Giãn tĩnh mạch cửa (Portal venous varix)
- Khí trong tĩnh mạch cửa (Portal venous gas)
- Màng ngăn tĩnh mạch chủ dưới (Inferior Vena Cava - IVC webs)
- Huyết khối tĩnh mạch chủ dưới (Inferior Vena Cava - IVC thrombosis)
-
Đường mật
-
Bệnh lý bẩm sinh
- Nang ống mật chủ (Choledochal Cyst)
- Bệnh Caroli và Hội chứng Caroli (Caroli disease)
- Bất sản túi mật (Gallbladder agenesis)
- Teo đường mật (Biliary Atresia - BA)
- Túi mật nhiều túi (Multiple Gallbladders)
- Ống mật đôi (Bile duct duplication)
- Túi mật có vách ngăn (Septate Gallbladder)
- Túi mật hình mũ Phrygian (Phrygian Cap)
- Túi thừa túi mật (Gallbladder Diverticula)
-
Bệnh lý viêm nhiễm
- Viêm túi mật hoại tử sinh hơi (Emphysematous Cholecystitis)
- Viêm gan mật mủ tái phát (Recurrent pyogenic cholangiohepatitis)
- Viêm đường mật cấp (Acute cholangitis)
- Giun đũa đường mật (Biliary ascariasis)
- Viêm đường mật do AIDS (AIDS cholangiopathy)
- Tụ mủ túi mật (Gallbladder empyema)
- Viêm túi mật cấp không sỏi (Acute acalculous cholecystitis)
- Viêm túi mật u hạt vàng (Xanthogranulomatous cholecystitis - XGC)
- Viêm đường mật tự miễn (IgG4-related sclerosing cholangitis - IgG4-RSC)
- Viêm xơ đường mật nguyên phát (Primary Sclerosing Cholangitis - PSC)
- Viêm túi mật cấp (Acute cholecystitis)
- Viêm túi mật hoại tử (Gangrenous cholecystitis)
- Viêm túi mật mạn tính (Chronic cholecystitis)
- Thủng túi mật (Gallbladder perforation)
- Viêm túi mật xuất huyết (Hemorrhagic cholecystitis)
- Viêm đường mật nguyên phát (Primary Biliary Cholangitis)
-
Bệnh lý sỏi mật
- Ứ nước túi mật (Gallbladder hydrops)
- Sỏi ống mật chủ (Choledocholithiasis - CBD)
- Sỏi bùn túi mật (Gallbladder sludge)
- Hội chứng Mirizzi (Mirizzi Syndrome)
- Bệnh cơ tuyến túi mật (Adenomyomatosis of the gallbladder)
- Ứ đọng Cholesterol thành túi mật (Gallbladder wall cholesterolosis)
- Túi mật sứ (Porcelain gallbladder)
- Lắng đọng sữa canxi ở túi mật (Milk of calcium gallbladder)/ Dịch mật vôi (Limy Bile)
- Sỏi túi mật (Gallstones)
- Sỏi đường mật trong gan (Hepatolithiasis)
-
Khối U đường mật
- Polyp túi mật (Gallbladder Polyps)
- Ung thư túi mật (Gallbladder Carcinoma)
- Ung thư bóng Vater (Ampullary Adenocarcinoma)
- U nhú trong ống mật (Intraductal Papillary Neoplasm of the Bile Duct - IPNB)
- Ung thư đường mật (Cholangiocarcinoma)
- U Klatskin (Ung thư đường mật vùng rốn gan)
- Lymphoma túi mật (Gallbladder lymphoma)
- U di căn túi mật (Gallbladder metastases)
- Phân loại giai đoạn ung thư túi mật (Gallbladder cancer staging)
- Phân loại giai đoạn ung thư đường mật trong gan (Intrahepatic cholangiocarcinoma (staging))
- Phân loại giai đoạn u đường mật vùng rốn gan Klatskin (Perihilar cholangiocarcinoma (staging))
-
Tụy
-
Bệnh lý viêm nhiễm
- Viêm tụy cấp (Acute Pancreatitis)
- Viêm tụy mạn (Chronic Pancreatitis)
- Tụy nhiễm mỡ (Pancreatic Lipomatosis)
- Viêm tụy rãnh tá tụy/ Viêm tụy cạnh tá tràng (Groove Pancreatitis)
- Viêm tụy tự miễn (Autoimmune Pancreatitis - AIP)
- Viêm tụy hoại tử (Necrotizing pancreatitis)
- Ổ tụ dịch cấp tính quanh tụy (Acute Peripancreatic Fluid Collection - APFC)
- Nang giả tụy (Pancreatic pseudocyst)
- Ổ tụ dịch hoại tử cấp tính (Acute Necrotic Collection - ANC)
- Hoại tử có vách (Walled-off Pancreatic Necrosis - WOPN hoặc WON)
- Teo nhu mô tụy (Pancreatic atrophy)
-
Khối u ở tụy
- U nang tuyến thanh dịch của tụy (Serous Cystadenoma of the Pancreas)
- Nang tụy đơn giản (Simple Pancreatic Cysts)
- Ung thư biểu mô tuyến ống tụy (Pancreatic Ductal Adenocarcinoma - PDAC)
- U nang tuyến nhầy của tụy (Mucinous Cystic Neoplasm - MCN)
- Carcinoma nang tuyến nhầy của tụy (Mucinous Cystadenocarcinoma - MCAC)
- U nhầy nhú trong ống tụy (Intraductal Papillary Mucinous Neoplasm - IPMN)
- U nội tiết tụy (Pancreatic Neuroendocrine Tumors - pNET)
- U đặc giả nhú của tụy (Solid Pseudopapillary Neoplasm - SPN)
- U di căn tụy (Pancreatic Metastases)
- Lymphoma tụy (Pancreatic Lymphoma)
- Ung thư biểu mô tế bào nang tuyến tụy (Pancreatic Acinar Cell Carcinoma - ACC)
- U mỡ tụy (Pancreatic Lipoma)
-
Phúc mạc, Mạc treo, và Thành bụng
-
Thoát vị nội
- Thoát vị cạnh tá tràng (Paraduodenal Hernia)
- Thoát vị Bochdalek (Bochdalek Hernia)
- Thoát vị Morgagni (Morgagni Hernia)
- Thoát vị thành bụng do chấn thương (Traumatic Abdominal Wall Hernia)
- Thoát vị nội sau phẫu thuật nối dạ dày (Internal Hernia due to Gastric Bypass Surgery)
- Thoát vị Nội (Internal Hernia)
- Thoát vị trên bàng quang (Internal Supravesical Hernia)
- Thoát vị mạc treo ruột non (Small Bowel Mesentery Internal Hernia)
- Thoát vị hậu cung mạc nối (Lesser sac hernia / Foramen of Winslow Hernia)
- Thoát vị quanh manh tràng (Pericaecal Hernia)
- Thoát vị mạc treo đại tràng sigma (Sigmoid Mesocolon Hernia)
- Thoát vị qua dây chằng rộng (Broad Ligament Hernia)
-
Bệnh lý mạch máu
- Phình động mạch tạng (Visceral Artery Aneurysms - VAA)
- Phình động mạch thân tạng (Celiac Artery Aneurysm - CAA)
- Phình động mạch mạc treo tràng dưới (Inferior Mesenteric Artery - IMA Aneurysm)
- Phình động mạch lách (Splenic Artery Aneurysm - SAA)
- Phình động mạch gan (Hepatic Artery Aneurysm - HAA)
- Phình động mạch thận (Renal Artery Aneurysm - RAA)
- Giả phình động mạch túi mật (Cystic Artery Pseudoaneurysm - CAP)
- Giả phình mạch quanh tụy (Peripancreatic Pseudoaneurysm)
- Giả phình động mạch thận (Renal Artery Pseudoaneurysm)
- Giả phình động mạch lách (Splenic Artery Pseudoaneurysm - SAPA)
-
Khối u phúc mạc
- Nang vùi phúc mạc (Peritoneal Inclusion Cyst)
- Nang mạc treo (Mesenteric cyst)
- U Desmoid mạc treo (Mesenteric desmoid tumor)
- U trung biểu mô phúc mạc ác tính (Malignant Peritoneal Mesothelioma)
- U di căn phúc mạc (Peritoneal Metastases)
- U giả nhầy phúc mạc (Pseudomyxoma peritonei - PMP)
- Lao phúc mạc (Tuberculous peritonitis)
- Lymphoma mạc treo (mesenteric lymphoma)
- Bánh mạc nối (Omental cake)
- U cơ trơn phúc mạc lan tỏa (Diffuse peritoneal leiomyomatosis)
-
Não
-
Bất thường bẩm sinh
-
Bất thường phát triển vỏ não
- Loạn dưỡng cơ bẩm sinh (Các biểu hiện ở hệ thần kinh trung ương) - Congenital muscular dystrophies (Central nervous system manifestations)
- Chất xám lạc chỗ (Grey Matter Heterotopia)
- Đầu nhỏ (Microcephaly)
- Đa hồi não nhỏ (Polymicrogyria)
- Loạn sản vỏ não khu trú (Focal Cortical Dysplasias - FCD)
- Nhẵn não (Lissencephaly)- CT,MRI
- Nứt não (Schizencephaly)
- To một bên bán cầu não (Hemimegalencephaly - HMEG)
-
Bệnh lý khối u/ thần kinh- da di truyền
- U xơ thần kinh type 1 (Neurofibromatosis type 1-NF1)
- U xơ thần kinh type 2 (Neurofibromatosis type 2- NF2)
- Von Hippel-Lindau (vHL)
- Bệnh xơ cứng củ ở não (Tuberous sclerosis)
- Hội chứng Sturge-Weber (Sturge-Weber syndrome)
- U mạch màng não (Meningioangiomatosis)
- Hội chứng Nevus Tế Bào Đáy (Basal Cell Nevus Syndrome - BCNS )/ Hội chứng Gorlin-Goltz (Gorlin-Goltz syndrome)
- Bệnh hắc tố thần kinh da (Neurocutaneous Melanosis -NCM)
- Hội chứng Aicardi (Aicardi syndrome)
- Hội chứng Li-Fraumeni (Li-Fraumeni syndrome)
- Bệnh u bao dây thần kinh bẩm sinh (Schwannomatosis)
- Hội chứng Turcot (Turcot Syndrome -TS)
- Hội chứng Louis-Bar (Thất điều giãn mạch/Ataxia-telangiectasia)
- Hội chứng PHACE (Hội chứng u máu da - phức hợp mạch máu) - PHACES Syndrome
-
Chấn thương
-
Tổn thương trực tiếp
- Tụ máu dưới màng xương (Cephalohematoma/subperiosteal hematoma)
- Tụ máu dưới cân Galea (Subgaleal hematoma)
- Bướu huyết thanh (Caput Succedaneum)
- Gãy sương sọ (Skull fractures)
- Vỡ lún xương sọ (Depressed Skull Fracture)
- Tổn thương xuyên thấu sọ não vận tốc thấp (Low-velocity penetrating brain injury)
- Chấn thương sọ não xuyên thấu do vật tốc độ cao (High-velocity penetrating brain injury)
- Xuất huyết ngoài màng cứng (Extradural Hemorrhage - EDH)/ Tụ máu ngoài màng cứng (Epidural Hematoma)
- Xuất huyết/Tụ máu dưới màng cứng (Subdural Hemorrhage/Hematoma - SDH)
- Xuất huyết dưới nhện do chấn thương (Traumatic Subarachnoid Hemorrhage - tSAH)
- Tụ máu ngoài màng cứng nguồn gốc tĩnh mạch (Venous Extradural Hemorrhage / Venous EDH)
- Dập não (Cerebral Contusion)
- Tổn thương sợi trục lan tỏa (Diffuse Axonal Injury - DAI)
- Phân độ tổn thương sợi trục lan tỏa(Diffuse Axonal Injury Grading)
- Chấn thương đầu do ngược đãi (Abusive head trauma - AHT)
- Xuất huyết não thất (Intraventricular Hemorrhage - IVH)
- Tràn khí nội sọ (Pneumocephalus)
- Gãy xương sọ trong tổn thương không do tai nạn (Skull fracture in Non-Accidental Injury - NAI)
-
Tổn thương gián tiếp
- Thoát vị não (Brain herniation)
- Thoát vị dưới liềm (Subfalcine Herniation - SFH)
- Thoát vị móc hải mã (Uncal Herniation)- Thoát vị xuyên lều xuống dưới một bên (Unilateral Descending Transtentorial Herniation)
- Thoát vị trung tâm (Central Herniation)-Thoát vị xuyên lều xuống dưới hai bên (Bilateral Descending Transtentorial Herniation)
- Thoát vị lều tiểu não hướng lên (Ascending Transtentorial Herniation)
- Thoát vị hạnh nhân tiểu não (Tonsillar Herniation)
- Thoát vị não ra ngoài sọ (Extracranial Brain Herniation)
- Thoát vị não nghịch thường (Paradoxical brain herniation)
- Thoát vị não vào hạt màng nhện (Brain herniation into arachnoid granulation - BHAG)
- Xuất huyết Duret (Duret hemorrhages)
- Phù não (Cerebral Edema)
- Phù não do mạch (Vasogenic Cerebral Edema)
- Phù độc tế bào (Cytotoxic Cerebral Edema)
- Phù quanh não thất / Phù mô kẽ (Transependymal Edema)
- Phù não hỗn hợp (Combined Cerebral Edema)
- Phù não thẩm thấu (Osmotic Cerebral Edema)
- Tổn thương mạch máu não-cổ do chấn thương kín (Blunt Cerebrovascular Injury - BCVI)
- Thang điểm Biffl phân loại tổn thương mạch máu não do chấn thương cùn (Blunt Cerebrovascular Injury - BCVI)
- Nang màng mềm (Leptomeningeal Cyst)/Vỡ sọ tiến triển (Growing Skull Fracture - GSF)
- Bệnh não chấn thương mạn tính (Chronic Traumatic Encephalopathy - CTE)
- Rò động mạch cảnh- xoang hang (Caroticocavernous Fistulas - CCFs)
-
-
Xuất huyết khoang dưới nhện và phình mạch não
-
Xuất huyết khoang dưới nhện
- Xuất huyết dưới nhện do vỡ phình mạch (Aneurysmal Subarachnoid Hemorrhage - aSAH)
- Xuất huyết dưới nhện quanh trung não không do phình mạch (Perimesencephalic Nonaneurysmal Subarachnoid Hemorrhage - pnSAH)
- Xuất huyết dưới nhện lồi não- cSAH (Convexal Subarachnoid Hemorrhage)
- Nhiễm sắt bề mặt kinh điển (Superficial Siderosis, Classical- SS)
- Nhiễm sắt bề mặt vỏ não (Cortical Superficial Siderosis- cSS)
-
Phình mạch não
- Phình mạch não dạng túi (Saccular cerebral aneurysm)
- Giãn quanh co động mạch sống- nền động mạch (Vertebrobasilar Dolichoectasia- VBD)
- Phình mạch nội sọ dạng hình thoi (Fusiform Intracranial Aneurysm)
- Phình mạch dạng mụn nước (Blood Blister-like Aneurysm- BBA)
- Phình mạch não do nhiễm trùng (Intracranial Mycotic Aneurysm / Intracranial Infectious Aneurysm)
-
-
Đột quỵ
-
Xuất huyết não không do chấn thương
- Vi xuất huyết não (Cerebral Microhemorrhage - CMB)
- Đột quỵ (Stroke)
- Xuất huyết trong nhu mô não tự phát không do chấn thương (Spontaneous Nontraumatic Intracranial Hemorrhage - pICH)
- Hình ảnh của xuất huyết não trên MRI(Hemorrhage on MRI)
- Protocol Chụp CT trong Đột Quỵ Cấp (Stroke Protocol - CT)
- Protocol chụp MRI trong đột quỵ cấp (Stroke Protocol - MRI)
- Xuất huyết não do tăng huyết áp (Hypertensive Intracerebral Hemorrhage - HICH)
- Xuất huyết tiểu não từ xa (Remote Cerebellar Hemorrhage - RCH)
- Xuất huyết vùng mầm (Germinal Matrix Hemorrhage - GMH)
-
Bệnh lý mạch máu không do xơ vữa
- Động mạch cảnh trong lạc chỗ (Aberrant Internal Carotid Artery)
- Tồn tại thông nối động mạch cảnh-nền (Persistent Carotid Basilar Anastomoses)
- Tồn tại động mạch sinh ba nguyên thủy (Persistent primitive trigeminal artery - PTA)
- Tồn tại động mạch hạ thiệt (Persistent hypoglossal artery - PHA)
- Tồn tại động mạch giáp trước/ Tồn tại động mạch trước đốt đột (Persistent proatlantal artery - ProA)
- Bệnh hồng cầu hình liềm (Biểu hiện ở não) - Sickle cell disease (cerebral manifestations)
- Bệnh Moyamoya (Moyamoya disease)
- Viêm động mạch nguyên phát hệ thần kinh trung ương (Primary Arteritis of the Central Nervous System- PACNS)
- Hội chứng co thắt mạch máu não có hồi phục (Reversible cerebral vasoconstriction syndrome - RCVS)
- Co thắt mạch não sau xuất huyết dưới nhện (Cerebral vasospasm following subarachnoid hemorrhage)
- Lupus thần kinh trung ương (Systemic lupus erythematosus - CNS manifestations)
- Bệnh vi mạch não dạng bột (Cerebral amyloid angiopathy - CAA)
- Bệnh lý viêm vi mạch não dạng bột (Cerebral Amyloid Angiopathy-Related Inflammation- CAA-RI )
- CADASIL
- Bệnh Behçet (Biểu hiện thần kinh trung ương) - Behçet disease (CNS manifestations)
- Hội chứng Susac (Susac Syndrome)
- Loạn sản sợi cơ (Fibromuscular Dysplasia - FD)
- Mạng lưới động mạch cảnh (Carotid web)
-
Nhồi máu não
- Não nước / Khuyết não bán cầu (Hydranencephaly)
- Tổn thương chất trắng ở trẻ non tháng (White Matter Injury of prematurity-WMI)/ Nhuyễn não chất trắng quanh não thất (Periventricular leukomalacia)
- Bệnh não do thiếu oxy-thiếu máu cục bộ ở trẻ sơ sinh (Neonatal Hypoxic-Ischemic Encephalopathy - HIE)
- Đột quỵ thiếu máu cục bộ động mạch ở trẻ em (Childhood Arterial Ischemic Stroke)
- Tổn thương não do thiếu oxy-thiếu máu cục bộ ở người lớn (Adult Hypoxic-Ischemic Injury - HII)
- Nhồi máu não do hạ huyết áp (Hypotensive Cerebral Infarction - HCI)/Nhồi máu vùng ranh giới (Border zone / Watershed infarction)/
- Teo nửa bán cầu đại não (Cerebral hemiatrophy)/Hội chứng Dyke-Davidoff-Masson (DDMS)
- Nhồi máu não do thiếu máu cục bộ (Ischemic stroke)
- Nhồi máu não đa ổ do thuyên tắc (Multiple Embolic Cerebral Infarctions)
- Nhồi máu não do thuyên tắc mỡ (Fat Emboli Cerebral Infarction)
- Thuyên tắc khí não (Cerebral Air Embolism - CAE)
- Nhồi máu lỗ khuyết (Lacunar Infarction - LI)
- Hội chứng tăng tưới máu não (Cerebral hyperperfusion syndrome - CHS)
- Huyết khối xoang tĩnh mạch màng cứng (Dural Venous Sinus Thrombosis - DVST)
- Dấu hiệu dây thừng trong huyết khối xoang tĩnh mạch màng cứng (Cord Sign)
- Dấu hiệu Tĩnh mạch Tăng Đậm Độ trong Huyết khối xoang tĩnh mạch màng cứng(Dense Vein Sign)
- Dấu hiệu Delta rỗng (huyết khối xoang tĩnh mạch màng cứng) - Empty delta sign (dural venous sinus thrombosis)
- Huyết khối tĩnh mạch vỏ não (Cortical Vein Thrombosis - CVT)
- Huyết khối tĩnh mạch não sâu (Deep cerebral vein thrombosis)
- Hạt màng nhện (Arachnoid Granulations)
- Hạt màng nhện lạc chỗ (Aberrant arachnoid granulations)
- Nhồi máu não giai đoạn cấp (Acute Cerebral Infarction)
- Nhồi máu não bán cấp (Subacute Cerebral Infarction)
- Nhồi máu não giai đoạn mạn tính (Chronic Cerebral Infarction)
-
-
Bất thường mạch máu
-
Đi kèm AV Shunting
- Dị dạng thông Động-Tĩnh mạch não (Brain Arteriovenous Malformation - AVM)
- Hệ thống phân độ dị dạng động-tĩnh mạch não Spetzler-Martin (Spetzler-Martin arteriovenous malformation grading system)
- Rò động-tĩnh mạch màng cứng (Dural Arteriovenous Fistula - DAVF)
- Dò động-tĩnh mạch màng mềm (Pial Arteriovenous Fistula - pAVF)
- Phân loại Yasargil cho dị dạng phình tĩnh mạch Galen (Yasargil classification of vein of Galen aneurysmal malformations)
- Bệnh lý tăng sinh mạch máu não (Cerebral Proliferative Angiopathy - CPA)
- Dị dạng phình tĩnh mạch Galen (Vein of Galen aneurysmal malformations - VGAMs)
-
Không đi kèm AV Shunting
- Xoang màng cứng da đầu (Sinus Pericranii)
- Bất thường phát triển tĩnh mạch (Developmental Venous Anomaly - DVA)
- Dị dạng thể hang ở não (Cerebral Cavernous Venous Malformations)
- Giãn mao mạch ở hệ thần kinh trung ương (CNS capillary telangiectasias)
- Huyết khối xoang hang (Cavernous sinus thrombosis - CST
-
-
U não
-
U tế bào hình sao lan tỏa (Astrocytic Tumors, Infltrating)
- U sao bào lan tỏa (Diffuse Astrocytoma)
- U sao bào thoái sản (Anaplastic Astrocytoma- AA)
- U nguyên bào thần kinh đệm (Glioblastoma- GBM)
- U thần kinh đệm lan tỏa toàn não (kiểu hình tăng trưởng) (Gliomatosis Cerebri- GC):
- U tế bào thần kinh đệm lan tỏa đường giữa, biến đổi H3 K27 (Diffuse midline glioma, H3 K27-altered)
-
U tế bào hình sao cục bộ (Astrocytic Tumors, Localized)
- U sao bào lông (Pilocytic Astrocytoma)
- U sao bào đa hình thái tế bào vàng (Pleomorphic Xanthoastrocytoma - PXA)
- U sao bào dạng nhầy lông (Pilomyxoid Astrocytoma- PMA)
- U sao bào khổng lồ dưới màng não thất (Subependymal Giant Cell Astrocytoma - SGCA/SEGA)
- U thần kinh đệm do xạ trị (Radiation-induced gliomas)
-
U tế bào thần kinh và U hỗn hợp tế bào thần kinh-thần kinh đệm (Neuronal and Mixed Neuronal-Glial Tumors)
- U tế bào thần kinh đệm hạch (Ganglioglioma)
- U hạch thần kinh đệm/u sao bào tạo mô đệm tân sản ở trẻ nhũ nhi (Desmoplastic Infantile Ganglioglioma/Astrocytoma)
- U tế bào thần kinh trung ương (Central Neurocytoma- CN)
- Hình ảnh bọt xà phòng (DNET) - Soap bubble appearance (DNET)
- Dấu hiệu viền sáng (DNET) - Bright rim sign (DNET)
- U thần kinh biểu mô loạn sản phôi (DNET) - Dysembryoplastic neuroepithelial tumors (DNET)
- U tế bào thần kinh ngoài não thất (Extraventricular neurocytoma - EVN)
- U nhú thần kinh đệm (Papillary glioneuronal tumors - PGNT)
- U tế bào thần kinh đệm hình hoa hồng (Rosette-forming glioneuronal tumors - RGNT)
- U thần kinh đệm màng mềm lan tỏa (Diffuse leptomeningeal glioneuronal tumor - DLGNT)
- U thần kinh đa nốt và tạo không bào (Multinodular and vacuolating neuronal tumors - MVNT)
- U tế bào hạch loạn sản tiểu não (Dysplastic Cerebellar Gangliocytoma)/Bệnh Lhermitte-Duclos (Lhermitte-Duclos Disease- LDD)
- U thần kinh biểu mô đa hình độ thấp ở người trẻ (Polymorphous Low-grade Neuroepithelial Tumor of the Young - PLNTY)
-
U mạch máu và U tạo máu (Blood Vessel and Hemopoietic Tumors)
- U lympho hệ thần kinh trung ương (Central Nervous System Lymphoma - CNS Lymphoma)
- U lympho hệ thần kinh trung ương liên quan đến suy giảm miễn dịch (Immunodeficiency-associated CNS lymphomas)
- U lympho nội mạch (Intravascular (angiocentric) lymphoma - IVL)
- Bệnh bạch cầu biểu hiện ở hệ thần kinh trung ương (Leukemia)
- U nguyên bào mạch máu hệ thần kinh trung ương - Hemangioblastoma (central nervous system)
-
-
Nang não
-
Các nang não nguyên phát
- Nang màng nhện (Arachnoid Cyst)
- Nang keo não thất ba (Colloid cysts of the third ventricle)
- Nang bì nội sọ (Intracranial dermoid cysts)
- Nang biểu bì nội sọ (Intracranial epidermoid cysts)
- Nang thần kinh đệm (Neuroglial cyst - NGC)
- Nang connatal (Connatal cyst)
- Nang khe mạch mạc (Choroidal Fissure Cyst)
- Nang di tích rãnh hồi hải mã (Hippocampal remnant cyst)
- Khoang quanh mạch (Perivascular spaces - PVSs)/Khoang Virchow-Robin (Virchow-Robin spaces)
- Nang tuyến tùng (Pineal cysts)
- Nang đám rối mạch mạc (Choroid plexus cyst - CPC)/ U hạt vàng đám rối màng mạch (Choroid plexus xanthogranulomata)
- Nang lỗ não (Porencephaly)
- Nang thần kinh ruột (Neurenteric cysts)
- Nang màng não thất (Ependymal cysts)
- Nang lành tính quanh u (Non-neoplastic tumor associated cysts - TACs)
-
-
Viêm/ Mất myelin
-
Nhiễm trùng mắc phải (Acquired Infections)
- Viêm màng não (Leptomeningitis)
- Áp xe não (Cerebral abscess)
- Viêm não thất (Ventriculitis)
- Tụ mủ dưới màng cứng (Subdural empyema)/Tụ mủ ngoài màng cứng (Epidural empyema - EDE)
- Viêm não do Herpes simplex (HSV) ở trẻ em và người lớn (Herpes simplex encephalitis)
- Viêm não do Virus (Viral Encephalitides)
- Viêm não do Virus Tây sông Nile (West Nile virus - WNV)
- Viêm não do Human herpesvirus 6 (HHV-6) - (HHV-6 Encephalitis/Encephalopathy)
- Viêm tiểu não cấp (Acute cerebellitis)
- Viêm não Rasmussen (Rasmussen encephalitis)
- Viêm não xơ cứng bán cấp (Subacute Sclerosing Panencephalitis - SSPE)
- Lao hệ thần kinh trung ương (Central nervous system tuberculosis - CNS-TB)
- Bệnh ấu trùng sán lợn ở hệ thần kinh (Neurocysticercosis)
- Bệnh Nang sán chó ở não (Neurohydatidosis)
- Bệnh amip hệ thần kinh trung ương (CNS amebiasis)
- Sốt rét thể não (Cerebral Malaria)
- Nhiễm nấm Aspergillus hệ thần kinh trung ương (CNS Aspergillosis)
- Nhiễm nấm Cryptococcus hệ thần kinh trung ương (CNS Cryptococcosis)
- Viêm não/Bệnh não do HIV (HIVE)
- Viêm não do Toxoplasma (Toxoplasmosis Encephalitis)
- Viêm não do mắc Cytomegalovirus - Cytomegalovirus encephalitis (CMV)
- Bệnh não chất trắng đa ổ tiến triển (Progressive Multifocal Leukoencephalopathy - PML)
- Bệnh não do virus JC (JC Virus Encephalopathy)
- Hội chứng viêm phục hồi miễn dịch (Immune Reconstitution Inflammatory Syndrome - IRIS)
- Sa sút trí tuệ liên quan HIV (HIV-associated dementia - HAD)
- Viêm não do virus Dengue (Dengue encephalitis)
-
Bệnh lý viêm và mất myelin (Inflammatory and Demyelinating Disease)
- Viêm não chất trắng xuất huyết cấp tính (Acute Hemorrhagic Leukoencephalitis- AHLE)
- Viêm não tủy rải rác cấp tính- ADEM (Acute Disseminated Encephalomyelitis - ADEM)
- Bệnh xơ cứng rải rác (Multiple Sclerosis- MS)
- Rối loạn phổ viêm tủy thị thần kinh (Neuromyelitis optica spectrum disorder - NMOSD)
- Viêm bạch huyết mạn tính với ngấm thuốc quanh mạch máu ở cầu não đáp ứng với steroid (CLIPPERS)
- Viêm não tự miễn (Autoimmune Encephalitis)
-
Chuyển hóa/thoái hóa di truyền
-
Bệnh não ty thể
- Bệnh não ty thể (Mitochondrial Encephalopathies -ME)
- Rối loạn ty thể nguyên phát (Primary mitochondrial disorders - PMDs)
- Các biểu hiện ở não của bệnh mucopolysaccharidoses (Cerebral manifestations of mucopolysaccharidoses)
- Bệnh loạn dưỡng chất trắng tế bào hình cầu (Globoid Cell Leukodystrophy)/ Bệnh Krabbe
- Bệnh Fabry (Fabry Disease)
- Rối loạn Peroxisome (Peroxisomal Disorders)/Hội chứng Zellweger (Zellweger Syndrome)
- Bệnh nước tiểu mùi si-rô phong (Maple syrup urine disease - MSUD)
- Bệnh Canavan (Canavan Disease)
- Bệnh loạn dưỡng chất trắng thượng thận liên kết nhiễm sắc thể X (X-linked Adrenoleukodystrophy)
- Nhiễm toan glutaric type 1 (Glutaric aciduria type 1)
- Bệnh Loạn dưỡng chất trắng thể não to kèm nang dưới vỏ (Megalencephalic Leukoencephalopathy with Subcortical Cysts - MLC)
- Thoái hóa thần kinh với tích tụ sắt trong não (Neurodegeneration with Brain Iron Accumulation - NBIA)
- Thoái hóa thần kinh liên quan đến Pantothenate Kinase (Pantothenate kinase-associated neurodegeneration - PKAN)
- Huntington Disease - HD
- Bệnh loạn dưỡng chất trắng dị sắc (Metachromatic Leukodystrophy - MLD)
- Bệnh Wilson- Biểu hiện ở não bộ (Wilson Disease)
-
-
Bệnh lý ngộ độc/chuyển hóa/thoái hóa mắc phải
-
Bệnh lý ngộ độc/chuyển hóa mắc phải
- Bệnh não do hạ đường huyết (Hypoglycemic encephalopathy)
- Co giật do tăng đường huyết không nhiễm toan ceton (Non-ketotic hyperglycemic seizures)
- Múa giật nửa người do tăng đường huyết không nhiễm ceton (Non-ketotic Hyperglycemic Hemichorea - NHH)
- Bệnh não do Bilirubin (Bilirubin Encephalopathy - BE)/Vàng da nhân (Kernicterus)
- Suy tuyến cận giáp- Biểu hiện ở não (Hypoparathyroidism)
- Giả suy tuyến cận giáp- Biểu hiện ở não (Pseudohypoparathyroidism)
- Bệnh não do rượu (alcoholic encephalopathy)/ Hội chứng Wernicke-Korsakoff (Wernicke-Korsakoff syndrome)
- Bệnh Marchiafava-Bignami (Marchiafava-Bignami Disease - MBD)/ Nghiện rượu mãn tính
- Bệnh Fahr (Fahr Disease- FD)
- Bệnh não gan (Hepatic Encephalopathy- HE)
- Bệnh não do urê huyết cao (Uremic Encephalopathy)
- PRES- Hội chứng bệnh não sau có hồi phục (Posterior Reversible Encephalopathy Syndrome )
- bệnh não do tăng huyết áp mạn tính (Chronic Hypertensive Encephalopathy)/Vi mạch do tăng huyết áp (Hypertensive Microangiopathy)
- Ngộ độc Carbon Monoxide (Carbon Monoxide Poisoning)
- Tổn thương não do lạm dụng chất (Drug Abuse)
- Ngộ độc Cyanide (Cyanide Poisoning)
- Độc tính thần kinh trung ương do Metronidazole (Metronidazole central nervous system toxicity)
- Lắng đọng Gadolinium (đối quang MRI) trong não (Gadolinium Deposition)
- Ngộ độc Methanol (Methanol Poisoning)
- Hội chứng hùy myelin do thẩm thấu (Osmotic Demyelination Syndrome - ODS)
- Bệnh lý mạch máu não do xạ trị (Radiation-induced cerebral vasculopathy - RICV)
- Biến chứng của xạ trị sọ (Complications of cranial radiation therapy)
- U màng não do xạ trị (Radiation-induced meningiomas)
- U thần kinh đệm do xạ trị (Radiation-induced gliomas)
- U sacrom (sarcoma) do xạ trị - Radiation-induced sarcoma (RIS)
- Giả tiến triển khối u sau điều trị (Tumor pseudoprogression)
- xơ cứng hồi hải mã (Hippocampal Sclerosis)/Xơ cứng thái dương trong (Mesial Temporal Sclerosis)
- Động kinh (Status Epilepticus- SE)
- Hội chứng mất trí nhớ toàn bộ thoáng qua (Transient Global Amnesia - TGA)
- Hiện tượng khối u giả đáp ứng sau điều trị (Pseudoresponse)
- Cường tuyến cận giáp ở sọ (Hyperparathyroidism)
-
Thoái hóa/ Sa sút trí tuệ
- Não lão hóa bình thường (Normal Aging Brain)
- Bệnh Alzheimer (Alzheimer Disease)
- Sa sút trí tuệ do mạch máu (Vascular dementia)
- Thoái hóa thùy trán- thái dương (Frontotemporal lobar degeneration- FTLD)
- Sa sút trí tuệ thể lewy (Dementia With Lewy Bodies - DLB)
- Bệnh Creutzfeldt-Jakob (Creutzfeldt-Jakob disease - CJD)
- Bệnh Parkinson (Parkinson Disease)
- Thoái hóa vỏ não hạch nền (Corticobasal Degeneration - CBD)
- Liệt trên nhân tiến triển (PSP - Progressive Supranuclear Palsy)
- Teo đa hệ thống (Multiple system atrophy - MSA)
- Bệnh xơ cứng teo cơ một bên (Amyotrophic lateral sclerosis - ALS)
- Thoái hóa Wallerian (Wallerian Degeneration)
- Suy giảm chức năng tiểu não đối bên (Crossed Cerebellar Diaschisis- CCD)
- Thoái hóa nhân trám phì đại (Hypertrophic Olivary Degeneration - HOD)
- Mất điều hòa tủy sống- tiểu não (Spinocerebellar Ataxia - SCAs)
- Run/mất điều hòa liên quan đến fragile x (Fragile X-Associated Tremor/Ataxia - FXTAS)
-
-
Bể não/Não thất
-
Não úng thủy
- Não úng thủy tắc nghẽn ở não thất (Obstructive Hydrocephalus)
- Não úng thủy tắc nghẽn ngoài não thất (EVOH - Extraventricular Obstructive Hydrocephalus)
- Hẹp cống não (Aqueductal Stenosis)
- Não úng thủy áp lực bình thường (NPH - Normal-Pressure Hydrocephalus)
- Dẫn lưu não thất-phúc mạc (Ventriculoperitoneal Shunt - VP)
- Dẫn lưu CSF quá mức (CSF overdrainage)
- Tổn thương thể chai sau não úng thủy (Post-hydrocephalus Corpus Callosum Damage)
-
Tuyến yên
-
Khối u
- U tuyến yên nhỏ (Pituitary microadenomas)
- Đột quỵ tuyến yên (Pituitary apoplexy)
- U sọ hầu dạng nhú (Papillary craniopharyngiomas)
- U sọ hầu dạng Adamantinoma (Adamantinomatous Craniopharyngioma)
- U tế bào tuyến yên (Pituicytoma)
- Spindle Cell Oncocytoma (SCO) của tuyến yên
- U tuyến yên lớn (Macroadenoma)
-
Sọ, Da đầu, Màng não
-
Giả u/Không phải u
- Viêm màng não phì đại liên quan đến IgG4 (IgG4-related hypertrophic pachymeningitis)
- Viêm tuyến yên liên quan đến IgG4 (IgG4-related hypophysitis)
- Loạn sản xơ sọ mặt (CFD - Craniofacial Fibrous Dysplasia)
- Dày hộp sọ (Calvarial thickening)
- Sarcoidosis thần kinh (Neurosarcoidosis)
- Nang bã nhờn (Sebaceous cyst - SC)/ Nang chân tóc (Trichilemmal cyst - TC)
- Bệnh Paget xương sọ - Paget disease (skull)
-
Khối U
- U màng não (Meningioma)
- U màng não không điển hình (Atypical Meningioma)
- U tế bào sợi đơn độc màng cứng (Solitary Fibrous Tumors - SFTs of the Dura)/U tế bào quanh mạch (Hemangiopericytoma - HPC)
- U xương dạng xương (Osteoma)
- U dây sống (Chordoma)
- U mạch máu vòm sọ (Skull Vault Hemangiomas - SVH)
- U mạch máu xoang hang (Cavernous Sinus Hemangioma)
- U sụn ác tính nền sọ (Chondrosarcomas of the base of the skull)
- U đa tủy ở sọ não (Myeloma)
- Di căn xương sọ (Skull Metastases)
-
-
Lồng ngực
-
Dấu hiệu và hình ảnh
-
Hình ảnh
- Nốt phế nang (Acinar Nodule)
- Dấu hiệu khí phế quản đồ (Air bronchogram)
- Dấu hiệu bẫy khí (Air-trapping)
- Khoảng khí (Airspace)
- Biến dạng cấu trúc phổi (Lung architectural distortion)
- Bóng khí phổi (Pulmonary bullae)/ Kén khí dưới màng phổi (Bleb)
- Hang phổi (Pulmonary cavity)
- Tổn thương trung tâm tiểu thùy (Centrilobular abnormalities)
- Đông đặc nhu mô phổi (Consolidation)
- Tổn thương dạng kính mờ (Ground-glass opacification - GGO)
- Tổn thương dạng tổ ong (Honeycombing)
- Dày vách liên tiểu thùy (Interlobular septal thickening)
- Nang phổi (Pulmonary Cyst)
- Tổn thương dạng khối ở phổi (Pulmonary Mass)
- Tổn thương dạng kê (Miliary pattern)
- Tổn thương dạng khảm (Mosaic attenuation)
- Nốt phổi (Pulmonary Nodules)
- Dày thành quanh mạch máu phế quản (Peribronchovascular Thickening)
- Tổn thương quanh mạch máu- phế quản (Peribronchovascular)
- Nốt phổi phân bố theo hệ bạch huyết (Perilymphatic lung nodules)
- Tổn thương dạng lưới (Reticular pattern)
- Tiểu thùy phổi thứ cấp (Secondary Pulmonary Lobule)
- Kén khí trong nhu mô phổi (Pneumatocele)
- Giãn phế quản do co kéo (Traction Bronchiectasis)
- Dấu hiệu chồi cây (Tree-in-bud pattern)
-
Dấu hiệu hình ảnh học
- Dấu hiệu liềm khí (Air Crescent Sign)
- Dấu hiệu cổ-ngực (Cervicothoracic Sign)
- Dấu hiệu đuôi sao chổi (Comet Tail Sign)
- Dấu hiệu quầng sáng (CT Halo Sign)
- Dấu hiệu ngón tay đeo găng (Finger-in-glove sign) (phổi)
- Dấu hiệu bánh Oreo (tim) - Oreo cookie sign (heart)/Dấu hiệu đệm mỡ màng ngoài tim (Fat Pad Sign)
- Dấu hiệu rãnh sâu (Deep Sulcus Sign) (ngực)
- Dấu hiệu hội tụ rốn phổi (Hilum Convergence Sign)
- Dấu hiệu che phủ rốn phổi (Hilum Overlay Sign)
- Dấu hiệu bờ không liên tục (phổi) - Incomplete border sign (chest)
- Dấu hiệu Luftsichel (Luftsichel sign)
- Dấu hiệu quầng sáng đảo ngược (Reversed halo sign)/Dấu hiệu đảo san hô (Atoll sign)
- Dấu hiệu Rigler/Dấu hiệu thành đôi (double-wall sign)
- Dấu hiệu Cupola (Bụng) - Cupola sign
- Dấu hiệu Golden S (Phổi) - Golden S-sign (lung)
- Dấu hiệu nhẫn kim cương (giãn phế quản )/Signet ring sign (bronchiectasis)
- Xẹp phổi do sẹo (Cicatrisation Atelectasis)
- Xẹp phổi tròn (Round atelectasis)
- Dấu hiệu xóa bờ (Silhouette Sign)
- Xẹp phổi (tổng quan) - Lung atelectasis
- Xẹp thùy dưới phổi trái (Left lower lobe atelectasis)
- Xẹp thùy trên phổi phải (Right upper lobe atelectasis)
- Xẹp thùy giữa phổi phải (Right middle lobe atelectasis)
- Xẹp thùy dưới phổi phải (Right lower lobe atelectasis)
- Xẹp thùy trên phổi trái (Left upper lobe atelectasis)
-
-
Bất thường phát triển bẩm sinh
-
Mạch máu Phổi
- Gián đoạn đoạn gần động mạch phổi (Proximal interruption of pulmonary artery - PIPA)/Bất sản động mạch phổi một bên (Unilateral absence of pulmonary artery - UAPA)
- Động mạch phổi trái lạc chỗ (Aberrant left pulmonary artery)/Vòng động mạch phổi (Pulmonary artery sling - PAS)
- Dị dạng động-tĩnh mạch phổi (Pulmonary arteriovenous malformation - PAVM)
- Bất thường hồi lưu tĩnh mạch phổi bán phần (Partial anomalous pulmonary venous return - PAPVR)
- Hội chứng Scimitar (Scimitar Syndrome)/Hội chứng thiểu sản phổi (Hypogenetic lung syndrome)
- Giãn tĩnh mạch phổi (Pulmonary venous varix - PVV)
-
Tuần hoàn hệ thống
- Thùy Azygos (Azygos lobe)/ Rãnh tĩnh mạch đơn (Azygos fissure)
- Tĩnh mạch đơn dẫn lưu cho tĩnh mạch chủ dưới (Azygos continuation of inferior vena cava - IVC)
- Tồn tại tĩnh mạch chủ trên trái (Persistent left superior vena cava - PLSVC)
- Cung động mạch chủ đôi (Double aortic arch)
- Động mạch dưới đòn phải lạc chỗ (Aberrant right subclavian artery)
- Cung động mạch chủ bên phải (Right-sided aortic arch)
- Hẹp eo động mạch chủ (Coarctation of the aorta - CoA)
-
Tim
- Thông liên nhĩ (Atrial Septal Defect - ASD)
- Thông liên thất (Ventricular Septal Defect - VSD)
- Van động mạch chủ hai lá van (Bicuspid Aortic Valve - BAV)
- Hẹp động mạch phổi bẩm sinh (Congenital Pulmonary Stenosis)
- Hội chứng đồng dạng (Heterotaxy syndrome)
- Bất sản màng ngoài tim (Pericardial Agenesis)
-
Bệnh lý đường thở (khí phế quản)
-
Dày thành, hẹp đường thở
- Khí quản hình vỏ kiếm (Sabre-sheath trachea)
- Hẹp khí quản (Tracheal Stenosis)
- Nhuyễn khí quản (Tracheomalacia)
- Hội chứng thùy giữa phải (Right middle lobe syndrome)
- Nhiễm amyloid khí phế quản (Tracheobronchial Amyloidosis)
- Bệnh cốt hóa-sụn khí phế quản (Tracheobronchopathia Osteochondroplastica - TO)
- Viêm đa sụn tái phát (Relapsing Polychondritis)
- Bệnh xơ cứng mũi (Rhinoscleroma)
- Bệnh u hạt kèm viêm đa mạch ở đường thở (Airway Granulomatosis with Polyangiitis - Airway GPA)/Bệnh Wegener ở đường thở (Wegener granulomatosis - WG)
-
Giãn, ứ đọng phế quản
- Bệnh phổi tắc nghẽn mạn tính (Chronic obstructive pulmonary disease - COPD)
- Giãn phế quản (Bronchiectasis)
- Xơ nang (Cystic Fibrosis)
- Viêm phế quản phổi dị ứng do nhiễm nấm Aspergillus (Allergic bronchopulmonary aspergillosis - ABPA)
- Rối loạn vận động nhung mao nguyên phát (Primary ciliary dyskinesia - PCD)
- Hội chứng Mounier-Kuhn (Mounier-Kuhn syndrome - MKS)/ Bệnh phình khí-phế quản (Tracheobronchomegaly)
- Hội chứng Williams-Campbell (Williams-Campbell Syndrome)
- Sỏi phế quản (Broncholith)
-
Khí phế thũng, bệnh đường thở nhỏ
- Khí phế thũng trung tâm tiểu thùy (Centrilobular Pulmonary Emphysema)
- Khí phế thũng cạnh vách (Paraseptal Emphysema)
- Khí phế thũng toàn tiểu thùy (Panlobular Emphysema)
- Viêm tiểu phế quản nhiễm trùng (Infectious Bronchiolitis)
- Viêm tiểu phế quản tắc nghẽn (Obliterative bronchiolitis)
- Hội chứng Swyer-James (Swyer-James syndrome)
- Hen suyễn (Asthma)
-
Nhiễm trùng
-
Vi khuẩn
- Viêm phổi do Klebsiella (Klebsiella Pneumonia)
- Viêm phổi do tụ cầu (Staphylococcal Pneumonia)
- Viêm phổi do phế cầu (Pneumococcal Pneumonia)
- Viêm phổi Legionella (Legionella pneumonia)
- Nocardiosis phổi (Pulmonary Nocardiosis)/ Viêm phổi do Nocardiosis
- Actinomycosis phổi (Thoracic Actinomycosis)
- Viêm phổi Melioidosis
- Viêm phổi do Mycobacterium không điển hình (Pulmonary non-tuberculous mycobacterial infection - NTM)/ Mycobacterium không phải lao
- Viêm phổi do Mycobacterium Avium (Pulmonary Mycobacterium avium complex infection - MAC)
- Viêm phổi do Mycoplasma pneumoniae/Viêm phổi không điển hình (atypical pneumonia)
- Lao phổi (Tuberculosis - Pulmonary Manifestations)
-
U phổi
-
Ung thư phổi
- Ung thư biểu mô tế bào vảy phổi (Squamous Cell Carcinoma of the Lung)
- Nốt phổi đơn độc (Solitary pulmonary nodule - SPN)
- Ung thư biểu mô tuyến phổi (Adenocarcinoma of the lung)
- Ung thư phổi tế bào nhỏ (Small cell lung carcinoma - SCLC)
- Ung thư phổi đa ổ nguyên phát đồng thời (Synchronous primary lung carcinoma - SPLC)
- Ung thư phổi đa ổ nguyên phát khác thời điểm (Metachronous primary lung carcinoma)
- Sàng lọc Ung thư Phổi (Lung Cancer Screening)
- U Pancoast (Pancoast tumor)
- Hệ thống phân giai đoạn ung thư phổi phiên bản 9 của IASLC (xuất bản năm 2025)
-
Khối u ít gặp
- Sarcoma Kaposi (KS)
- U thần kinh nội tiết của phổi (Pulmonary neuroendocrine tumors)
- U carcinoid phổi ngoại biên (Peripheral Pulmonary Carcinoid Tumor)
- Ung thư biểu mô thần kinh nội tiết tế bào lớn của phổi (Large cell neuroendocrine carcinoma - LCNEC)
- U Carcinoid phế quản (Bronchial Carcinoid Tumors)/ U thần kinh nội tiết phế quản
- U mô thừa phổi (Pulmonary Hamartomas)
-
-
Bệnh phổi mô kẽ, lan tỏa và hít phải
-
Bệnh phổi mô kẽ
- Hội chứng suy hô hấp cấp tiến triển (ARDS)
- Viêm phổi kẽ cấp tính (Acute Interstitial Pneumonia - AIP)
- Xơ phổi vô căn (Idiopathic pulmonary fibrosis - IPF)/Viêm phổi kẽ thông thường vô căn (Idiopathic usual interstitial pneumonia - UIP)
- Viêm phổi kẽ không đặc hiệu (Non-specific interstitial pneumonia - NSIP)
- Viêm phổi tổ chức hóa (Organizing Pneumonia - OP)
- Sarcoidosis phổi (thoracic manifestations)
- Tăng sinh sợi đàn hồi màng phổi-phổi (Pleuroparenchymal fibroelastosis - PPFE)
-
Bệnh lý do hút thuốc
- Viêm phổi kẽ tróc vảy (Desquamative interstitial pneumonia - DIP)
- Hội chứng xơ hóa phổi và khí phế thũng kết hợp (Combined Pulmonary Fibrosis and Emphysema - CPFE)
- Viêm tiểu phế quản hô hấp (Respiratory Bronchiolitis)
- Bệnh phổi kẽ liên quan đến viêm tiểu phế quản hô hấp (Respiratory Bronchiolitis Interstitial Lung Disease - RB-ILD)
- Bệnh mô bào Langerhans ở phổi (Pulmonary Langerhans Cell Histiocytosis - PLCH)
-
Bệnh bụi phổi
- Bệnh bụi phổi amiăng (Asbestosis)
- Bệnh bụi phổi do kim loại nặng (Hard Metal Pneumoconiosis)/Viêm phổi kẽ tế bào khổng lồ (Giant cell interstitial pneumonia - GIP)
- Bệnh bụi phổi Silic (Silicosis)/Bệnh bụi phổi công nhân mỏ than (Coal Worker's Pneumoconiosis - CWP)
- Khối xơ hóa tiến triển (Progressive massive fibrosis - PMF)
-
Bệnh lý chuyển hóa và các bệnh khác
- Bệnh vi sỏi phế nang phổi (Pulmonary alveolar microlithiasis - PAM)
- Vôi hóa phổi di căn (Metastatic pulmonary calcification - MPC)
- Bệnh phổi thoái hóa dạng bột (Amyloidosis pulmonary)
- Viêm phổi do mỡ (Lipoid pneumonia - LP)
- Bệnh lắng đọng protein phế nang phổi (Pulmonary alveolar proteinosis - PAP)
- Bệnh cơ trơn mạch bạch huyết (Lymphangioleiomyomatosis - LAM)
- Cốt hóa phổi dạng cành cây (Dendriform pulmonary ossification - DPO)
-
-
Bệnh Rối Loạn Mô Liên Kết, Miễn Dịch và Viêm Mạch
-
Các Rối Loạn Miễn Dịch và Mô Liên Kết
- Viêm khớp dạng thấp biểu hiện ở phổi (Rheumatoid arthritis - RA)/ Bệnh phổi dạng thấp (Rheumatoid lung)
- Xơ cứng bì (biểu hiện ở phổi) - Scleroderma (pulmonary manifestations)
- Bệnh mô liên kết hỗn hợp (Biểu hiện ở phổi) - Mixed connective tissue disease (pulmonary manifestations)
- Viêm đa cơ (biểu hiện ở phổi) - Polymyositis (pulmonary manifestations)
- Bệnh lupus ban đỏ hệ thồng (biểu hiện ở ngực) - Systemic lupus erythematosus (thoracic manifestations)
- Hội chứng Sjögren (Biểu hiện ở ngực) - Sjögren syndrome (thoracic manifestations)
- Viêm cột sống dính khớp (Biểu hiện ở phổi) - (Ankylosing spondylitis- thoracic manifestations)
- Erdheim-Chester disease (pulmonary manifestations)
-
Xuất huyết và viêm mạch
- Bệnh lắng đọng hemosiderin phổi vô căn (Idiopathic pulmonary hemosiderosis - IPH)/ Xuất huyết phổi vô căn
- Hội chứng Goodpasture (Goodpasture Syndrome)
- Bệnh u hạt kèm viêm đa mạch (Biểu hiện tại lồng ngực) - Granulomatosis with polyangiitis (thoracic manifestations)
- Bệnh u hạt tăng bạch cầu ái toan kèm viêm đa mạch (Biểu hiện tại lồng ngực) - Eosinophilic granulomatosis with polyangiitis (EGPA)
- Bệnh Behçet (Biểu hiện ở lồng ngực)
-
-
Bất thường trung thất
-
Khối u nguyên phát
- U tuyến ức (Thymoma)
- U Carcinoid/nội tiết thần kinh tuyến ức - Carcinoid/neuroendocrine tumors of the thymus
- Ung thư biểu mô tuyến ức (Thymic carcinoma)
- U mỡ tuyến ức (Thymolipoma)
- U quái trung thất (Mediastinal Teratoma)
- U Tinh (Seminoma) trung thất (Mediastinal Seminoma)
- U túi noãn hoàng trung thất (Mediastinal yolk sac tumor)/U tế bào mầm không phải Seminoma (Nonseminomatous germ cell tumor - NSGCT)
- U tế bào mầm thể hỗn hợp ở trung thất (Mediastinal mixed germ cell tumor)/U tế bào mầm không phải Seminoma (Nonseminomatous germ cell tumor - NSGCT)
- U bao dây thần kinh (Neurogenic neoplasms of the nerve sheath)
- Bệnh đa u sợi thần kinh type 1 (Neurofibromatosis type 1 - NF1)
- U nguyên bào thần kinh hạch ở trung thất (Ganglioneuroblastoma)
- U nguyên bào thần kinh ở trung thất (Neuroblastoma)
- U hạch thần kinh (Ganglioneuroma)
-
-
Tim mạch
-
Tăng áp phổi và Thuyên tắc
- Tăng áp động mạch phổi (Pulmonary artery hypertension - PAH)
- Hội chứng ngực cấp tính trong bệnh hồng cầu hình liềm - Sickle cell disease (acute chest syndrome)
- Tăng áp động mạch phổi do huyết khối mãn tính (Chronic Thromboembolic Pulmonary Hypertension - CTEPH)
- Bệnh lý thuyên tắc huyết khối động mạch phổi cấp (Acute Pulmonary Thromboembolic Disease)
- Tắc nghẽn tĩnh mạch phổi (Pulmonary veno-occlusive disease - PVOD)/ Bệnh u máumao mạch phổi (Pulmonary capillary hemangiomatosis -PCH)
- Tắc mạch phổi do mỡ (Pulmonary Fat Embolism)/Thuyên tắc mỡ (Fat Embolism - FE)
- Hội chứng gan-phổi (Hepatopulmonary syndrome - HPS)
- Các biểu hiện ở phổi do sử dụng chất gây nghiện (Illicit Drug Use, Pulmonary Manifestations)
-
Bệnh lý tim và màng ngoài tim
- Vôi hóa vòng van hai lá (Mitral annular calcification)
- Hẹp van động mạch chủ (Aortic valve stenosis)
- Hở van hai lá (Mitral Valve Regurgitation)
- Hẹp van hai lá (Mitral Valve Stenosis)
- Vôi hóa nhĩ trái (Left Atrial Calcification)
- Bệnh động mạch vành (Coronary Artery Disease - CAD)
- Tràn dịch màng ngoài tim (Pericardial Effusions)
- Viêm màng ngoài tim co thắt (Constrictive Pericarditis)
-
Chấn thương
-
Màng phổi, Thành ngực, và Cơ hoành
- Tràn máu màng phổi do chấn thương (Traumatic Hemothorax)
- Tràn khí màng phổi do chấn thương (Traumatic pneumothorax)
- Lách lạc chỗ khoang màng phổi (Thoracic splenosis)
- Gãy xương sườn (Rib fractures)
- Mảng sườn di động (Flail chest)
- Gãy cột sống (Spinal Fracture)
- Gãy xương ức (Sternal fracture)
- Vỡ cơ hoành (Diaphragmatic Rupture)
-
Sau điều trị
-
Dụng cụ bên ngoài
- Ống mở khí quản (Tracheostomy Tubes)
- Ống dẫn lưu màng ngoài tim
- Ống thông liên sườn (Intercostal catheters - ICC)
- Ống nội khí quản (Endotracheal tubes - ETT)
- Đường truyền và ống thông (trên X-quang) - Lines and tubes (radiograph)
- Các thiết bị tạo nhịp tim (Cardiac Conduction Devices)
- Catheter tĩnh mạch trung tâm (Central venous catheter - CVC)
- Catheter trung tâm đặt từ tĩnh mạch ngoại vi (Peripherally Inserted Central Catheter - PICC)
- Bóng đối xung trong động mạch chủ (Intra-aortic balloon pump - IABP)
-
Phẫu thuật và biến chứng
- Kỹ thuật làm dính màng phổi (Pleurodesis)
- Phẫu thuật giảm thể tích phổi (LUNG VOLUME REDUCTION SURGERY - LVRS)
- Phẫu thuật cắt thùy phổi (Lobectomy)
- Xoắn phổi (Lung torsion)
- Phẫu thuật cắt toàn bộ phổi (Pneumonectomy)
- Phẫu thuật tạo hình lồng ngực (Thoracoplasty)
- Thoát vị phổi (Lung Herniation)
- Phẫu thuật mở xương ức - Sternotomy
- Ghép tim (Heart transplantation)
- Ghép phổi - Lung transplant
- Phẫu thuật cắt thực quản (Esophagectomy)
-
-
Màng phổi
-
Khối u màng phổi
- Tràn dịch màng phổi ác tính (Malignant Pleural Effusion - MPE)
- Nốt di căn màng phổi (Solid Pleural Metastases)
- U trung biểu mô màng phổi ác tính (Malignant Pleural Mesothelioma - MPM)
- Hệ thống phân giai đoạn TNM lần thứ tám cho U trung biểu mô màng phổi ác tính - Malignant pleural mesothelioma (TNM staging)
- U xơ khu trú của màng phổi (Localized Fibrous Tumor of the Pleura - LFTP)
-
Hình ảnh học bình thường
-
Hình ảnh học bình thường
- X-quang ngực thẳng bình thường (Chest Radiograph)
- X-quang ngực tư thế nghiêng (Chest - lateral view)
- Hình ảnh chụp cắt lớp CT ngực (Computed tomography of the chest)
- Vị trí bình thường của vòm hoành trên X-quang ngực (Normal position of hemidiaphragms on chest radiography)
- Đường viền bình thường của bóng tim và trung thất trên X-quang ngực (Normal contours of the cardiomediastinum on chest radiography)
- Giải phẫu phân thùy phế quản-phổi (Bronchopulmonary segmental anatomy)
-
-
-
Cơ xương khớp
-
Vai và cánh tay
-
Tổn thương xương và khớp
- Trật khớp ức đòn (Sternoclavicular joint injury)
- Gãy xương đòn (Clavicular fractures)
- Gãy xương bả vai (Scapula fractures)
- Trật khớp vai ra trước (Anterior shoulder dislocation)
- Trật khớp vai ra sau (Posterior shoulder dislocations)
- Trật khớp vai xuống dưới (Inferior shoulder dislocation)
- Hội chứng vai của cầu thủ ném bóng nhí- Little Leaguer's Shoulder
- Trật khớp cùng - đòn (Acromioclavicular joint injuries)
- Gãy mấu động lớn xương cánh tay (Greater tubercle fracture of the shoulder)
- Tiêu đầu xa xương đòn (Distal clavicle osteolysis)
- Tổn thương sụn-xương ở vai (Osteochondral Injury, Shoulder)
- Gãy đầu trên xương cánh tay (Proximal humeral fracture)
- Gãy thân xương cánh tay (Humeral Shaft Fracture)
- Mỏm cùng vai phụ (Os acromiale)
-
Tổn thương chóp xoay
- Hội chứng chèn ép dưới mỏm cùng vai (Subacromial impingement)
- Rách chóp xoay bán phần (Partial-thickness rotator cuff tear)
- Rách chóp xoay toàn phần (Rotator Cuff Full-Thickness Tear)
- Rách gân cơ trên gai (Supraspinatus tendon tear)
- Rách gân cơ dưới gai (Infraspinatus tendon tear)
- Rách khoảnh trống chóp xoay (Rotator Interval Tear)
- Rách gân cơ dưới vai (Subscapularis tendon tear)
- Chóp xoay sau phẫu thuật (Rotator cuff repair)
- Viêm gân vôi hóa chóp xoay (Calcific tendinitis)
-
Bệnh lý sụn viền và mất vững
- Tổn thương Bankart (Bankart Lesion)/ Rách sụn viền trước dưới
- Viêm dính bao khớp vai (Adhesive capsulitis of the shoulder)
- Tổn thương ALPSA (Anterior Labrum Periosteal Sleeve Avulsion)
- Tổn thương Perthes (Perthes lesion)
- Tổn thương GLAD rách sụn viền-mặt khớp (Glenolabral Articular Disruption)
- Tổn thương HAGL (Humeral Avulsion of the Glenohumeral Ligament)/ Bong dây chằng ổ chảo-cánh tay dưới
- Tổn thương GAGL (Glenoid Avulsion of the Glenohumeral Ligament)
- Tổn thương Bennett ở vai (Bennett lesion of the shoulder)
- Rách sụn viền ổ chảo phía sau (Reverse Bankart lesion)
- Mất vững khớp vai đa hướng (Multidirectional shoulder instability)
-
-
Khuỷu tay và cẳng tay
-
Xương và khớp
- Gãy đầu dưới xương cánh tay (Distal Humerus Fracture)
- Gãy trên lồi cầu xương cánh tay (Supracondylar Humeral Fracture)
- Gãy lồi cầu ngoài xương cánh tay (Lateral humeral condyle fracture)
- Gãy mỏm trên lồi cầu trong (Medial epicondyle fracture)
- Gãy chỏm con xương cánh tay (Capitellum fracture)
- Trật khớp khuỷu (Elbow Dislocation)
- Gãy Monteggia ( gãy trật khớp khủy)
- Viêm sụn-xương bóc tách ở khuỷu (Osteochondritis Dissecans - OCD)
- Gãy chỏm xương quay (Radial head fracture)
- Gãy cổ xương quay (Radial neck fracture)
- Gãy mỏm khuỷu (Olecranon Fracture)
- Gãy mỏm vẹt (Coronoid Fracture)
- Gãy xương cẳng tay (Forearm Fractures)
- Gãy Galeazzi (Galeazzi fracture-dislocation)
- Gãy-trật Essex-Lopresti (Essex-Lopresti fracture-dislocation)
-
Tổn thương dây chằng
- Tổn thương phức hợp dây chằng bên ngoài (Lateral Collateral Ligament - LCL complex)
- Tổn thương dây chằng vòng (Annular ligament)
- Tổn thương dây chằng bên trụ (Ulnar Collateral Ligament- UCL)
- Tổn thương khuỷu tay do stress vẹo ngoài/Khuỷu tay của cầu thủ ném bóng nhí (Valgus Stress Mechanism/Little Leaguer's Elbow)
-
Tổn thương gân cơ
- Tổn thương gân cơ nhị đầu ở khuỷu (Biceps Tendon Injury, Elbow)
- Tổn thương gân cơ tam đầu vùng khuỷu (Triceps Tendon Injury, Elbow)
- Tổn thương gân duỗi chung ở khuỷu (Common Extensor Tendon Injury)
- Tổn thương gân gập-sấp chung (Common Flexor-Pronator Tendon Injury)
- Tổn thương cơ cánh tay (Brachialis Injury)
-
Tổn thương khác
- Mảnh vỡ trong khớp khuỷu (Intraarticular Bodies, Elbow)
- Hội chứng nếp hoạt dịch (Synovial fold syndrome - SFS)
- Hội chứng chẹn sau của khuỷu (Posterior Impingement, Elbow)/Hội chứng quá duỗi mỏm khuỷu (Valgus Extension Overload- VEO)
- Viêm bao hoạt dịch khuỷu tay (Olecranon Bursitis)
- Viêm bao hoạt dịch nhị đầu-quay (Bicipitoradial Bursitis)
- Tổn thương thần kinh trụ ở khuỷu (Ulnar Nerve Injury, Elbow)
- Tổn thương thần kinh giữa ở khuỷu (Median Nerve Injury, Elbow)
- Tổn thương thần kinh quay ở khuỷu (Radial Nerve Injury, Elbow)
-
-
Cổ tay và bàn tay
-
Tổn thương xương- khớp cẳng tay
- Gãy xương cẳng tay dưới ở trẻ em (Juvenile Distal Forearm Fractures)
- Gãy phình vỏ xương cẳng tay (Buckle fracture).
- Gãy cành tươi (Greenstick fracture)
- Gãy cong (Bowing fracture)
- Gãy đầu dưới xương quay (Distal radial fracture)
- Gãy Colles (Colles fracture)
- Gãy Smith (Smith fracture)
- Gãy Barton (Barton fracture)
- Gãy Chauffeur (Chauffeur fracture)
- Gãy lún mặt nguyệt xương quay (Die-Punch Fracture)
- Tổn thương sụn tiếp hợp do quá tải ở cổ tay trẻ em (Trauma-Related Osteolysis, Pediatric Wrist)
- Mất vững khớp quay trụ dưới (Distal Radioulnar Joint Instability)
- Độ nghiêng xương quay (Radial inclination)
- Độ nghiêng lòng tay (Volar tilt)
- Gãy mỏm trâm trụ (Ulnar styloid fracture)
-
Tổn thương xương- khớp cổ tay
- Giải phẫu xương cổ tay (Carpal bones)
- Gãy xương thuyền (Scaphoid Fracture)
- Khớp giả xương thuyền (Scaphoid non-union)
- Hội chứng SNAC ở xương thuyền (Scaphoid Non-union Advanced Collapse)
- Hoại tử vô mạch xương thuyền (scaphoid osteonecrosis)
- Gãy xương tháp (Triquetral fracture)
- Gãy xương thang (Trapezium fracture)
- Gãy xương nguyệt (Lunate fracture)
- Gãy xương cả (Capitate fracture)
- Gãy xương móc (Hamate fracture)
- Gãy xương đậu (Pisiform fracture)
- Gãy xương thê (Trapezoid fracture)
- Hoại tử vô mạch xương nguyệt (Kienböck disease)
- Hội chứng SLAC ở xương thuyền- nguyệt(Scapholunate Advanced Collapse)
- Biến dạng lưng gù của xương thuyền (Humpback deformity of the scaphoid)
-
Trật khớp cổ tay
- Ba cung cổ tay của Gilula (Gilula's three carpal arcs)
- Góc Cả-Nguyệt (Capitolunate angle)
- Góc Thuyền-Nguyệt (Scapholunate angle)
- Mất vững về phía lòng tay từng đoạn (Volar Intercalated Segment Instability - VISI)
- Mất vững về phía mu tay từng đoạn (Dorsal Intercalated Segment Instability - DISI)
- Trật xương nguyệt (Lunate dislocation)
- Trật quanh nguyệt (Perilunate dislocation)
- Mất vững thuyền-nguyệt (Scapholunate dissociation)
- Trật khớp giữa các hàng xương cổ tay (Midcarpal dislocation)
- Phân loại Mayfield về mất vững khối xương cổ tay (Mayfield classification of carpal instability)
-
Tổn thương xương- khớp ngón tay
- Gãy xương ngón tay đốt gần (Proximal phalanx fracture)
- Gãy xương ngón tay đốt giữa (Middle phalanx fracture)
- Gãy đốt xa xương ngón tay (Distal phalanx fracture)
- Ngón tay búa (Mallet finger)
- Ngón tay Jersey (Jersey finger)
- Trật khớp ngón tay (Interphalangeal joint dislocation)
- Gãy bong ở mặt lòng tay (Volar plate avulsion injury)
-
Tổn thương dây chằng và gân cơ
- Các khoang duỗi cổ tay (Extensor compartments of the wrist)
- Tổn thương phức hợp sụn sợi tam giác (Triangular fibrocartilage complex - TFCC injury)
- Đứt dây chằng thuyền-nguyệt (Scapholunate ligament tear)
- Viêm bao gân De Quervain (De Quervain tenosynovitis)
- Hội chứng giao thoa gân duỗi gần (Proximal intersection syndrome)
- Hội chứng giao thoa gân duỗi xa (Distal intersection syndrome)
- Bệnh lý gân duỗi cổ tay trụ (Extensor Carpi Ulnaris - ECU tendinopathy)
- Tổn thương dây chằng bên của ngón tay (Collateral ligament injury of finger)
-
-
Khớp háng và Xương chậu
-
Tổn thương khớp háng và đầu trên xương đùi
- Trật khớp háng ra trước (Anterior hip dislocation- AHD)
- Trật khớp háng ra sau (Posterior hip dislocation - PHD)
- Gãy chỏm xương đùi (Femoral Head Fracture)
- Gãy cổ xương đùi (Femoral Neck Fracture)
- Gãy vùng mấu chuyển (Trochanteric fracture)
- Phân loại Garden gãy cổ xương đùi
- Gãy mấu chuyển lớn xương đùi (Isolated greater trochanteric fracture)
- Gãy thân xương đùi (Femoral Shaft Fracture)
- Gãy xương đùi liên quan đến bisphosphonate (Atypical femoral fracture)
-
Tổn thương xương chậu
- Tiếp cận X- quang xương chậu
- Gãy ổ cối (Acetabular fracture)
- Gãy xương chậu (Pelvic fractures)
- Gãy bong sụn tiếp hợp ở háng và chậu (Apophyseal avulsion fractures of the pelvis and hip)
- Gãy xương chậu do suy yếu (Pelvic insufficiency fracture)/ Gãy xương chậu do stress
- Gãy xương cùng (Sacral fractures)
- Gãy xương cùng do suy yếu (Sacral insufficiency fracture)/ gãy xương cùng do mỏi (stress fracture)
-
Hoại tử chỏm và khớp háng nhân tạo
- Loãng xương thoáng qua khớp háng (Transient osteoporosis of the hip)
- Hoại tử vô mạch chỏm xương đùi (Osteonecrosis of the femoral head)
- Thay khớp háng bán phần (Hip hemiarthroplasty)
- Thay khớp háng toàn phần (Total Hip Arthroplasty - THA)
- Biến chứng thay khớp háng (Total hip arthroplasty complications)
- Tái tạo bề mặt khớp háng (Hip resurfacing arthroplasty)
-
Tổn thương dây chằng và gân cơ
- Tổn thương dây chằng tròn (Ligamentum teres injury)
- Tổn thương gân cơ mông (Gluteal tendinopathy)(nhóm cơ dạng háng)
- Tổn thương cơ thẳng đùi (Rectus femoris muscle injuries)(nhóm cơ gập háng)
- Tổn thương cơ Hamstring (gân chân ngỗng)(nhóm cơ duỗi háng)
- Tổn thương cơ khép dài (Adductor longus)(nhóm cơ khép háng)
- Đau bẹn ở vận động viên (Athletic Pubalgia)
- Viêm xương mu (Osteitis pubis)
-
Hội chứng chẹn và khớp kêu
- Hội chứng dải chậu-chày ở khớp háng (Proximal iliotibial band syndrome)
- Hội chứng khớp háng kêu (Snapping hip syndrome)
- Háng kêu do gân cơ thắt lưng chậu (Snapping iliopsoas tendon)
- Hội chứng kẹt (chẹn) ụ ngồi-xương đùi (Ischiofemoral impingement)
- Hội chứng kẹt (chẹn) xương đùi-ổ cối (Femoroacetabular Impingement - FAI)
- Biến dạng Cam ở chỏm xương đùi (Trong hội chứng chẹn xương đùi- ổ cối) (Cam morphology - femoroacetabular impingement)
- Hình thái Pincer (Kìm) của ổ cối (trong hội chứng kẹt xương đùi-ổ cối)
- Lún ổ cối (Acetabular protrusion)
-
-
Khớp gối
-
Tổn thương xương và khớp gối
- Gãy đầu dưới xương đùi (Distal femoral fracture)
- Gãy mâm chày (Tibial Plateau Fracture)
- Gãy Hoffa (gãy lồi cầu xương đùi)
- Trật khớp gối (Knee dislocation)
- Gãy Maisonneuve (gãy đầu trên xương mác)
- Gãy thân xương chày (Tibial shaft fracture)
- Hội chứng stress mặt trong xương chày (Medial Tibial Stress Syndrome - MTSS)
- Gãy xoắn xương chày ở trẻ em (Toddler fracture)
- Chấn thương sụn xương khớp gối (Osteochondral Injury, Knee)
- Bong tách sụn khớp gối (Chondral delamination)
- Gãy sụn khớp gối (Chondral Fracture)
- Gãy xương dưới sụn do mỏi ở gối (Subchondral insufficiency fracture of the knee - SIFK)
- Dập xương ở gối (Patterns of bone bruise in knee injury)
- Viêm sụn-xương bóc tách ở khớp gối (Osteochondritis dissecans of the knee)
-
Gãy bong khớp gối
- Gãy bong điểm bám dây chằng chéo trước (Anterior cruciate ligament avulsion fracture- ACL)
- Gãy bong điểm bám dây chằng chéo sau ở xương chày (Posterior cruciate ligament avulsion fracture)
- Gãy Stieda/ Gãy bong điểm bám dây chằng MCL vào lồi cầu trong xương đùi
- Gãy Segond ngược/Gãy bong mâm chày trong
- Gãy bong phức hợp dây chằng cung (Dấu hiệu Arcuate)
- Gãy Segond (Gãy bong mâm chày do đứt ACL)
- Gãy bong điểm bám đầu xa gân cơ bán mạc (Semimembranosus distal tendon avulsion)
- Bệnh Osgood-Schlatter (viêm lồi củ chày)
- Bệnh Sinding-Larsen-Johansson (SLJ)
- Bệnh lý gối do nhảy (Jumper's knee)
-
Tổn thương xương bánh chè
- Xương bánh chè hai mảnh (Bipartite patella)
- Xương bánh chè nhiều mảnh (Multipartite patella)
- Phân loại Wiberg về hình dáng xương bánh chè
- Khuyết mặt sau xương bánh chè (Dorsal defect of the patella)
- Gãy xương bánh chè (Patellar fracture)
- Trật xương bánh chè ra ngoài (Lateral patellar dislocation)
- Mất vững khớp bánh chè-đùi (Patellofemoral instability)
- Xương bánh chè nằm thấp (Patella baja)
- Xương bánh chè nằm cao (Patella alta)
- Nhuyễn sụn xương bánh chè (Chondromalacia patellae)
- Hội chứng Móng-Xương bánh chè (Nail-patella syndrome)
- Gãy bong xương bánh chè (Patellar sleeve fracture)
- Đứt gân bánh chè (Patellar tendon rupture)
-
Tổn thương dây chằng và gân cơ
- Rách dây chằng chéo trước ACL (Anterior cruciate ligament tear)
- Rách dây chằng chéo trước (ACL) mạn tính
- Thoái hóa nhầy của dây chằng chéo trước (Anterior cruciate ligament (ACL) mucoid degeneration)
- Bộ ba bất hạnh của O'Donoghue (O'Donoghue unhappy triad)
- Phẫu thuật dây chằng chéo trước (Anterior cruciate ligament reconstruction)
- Rách dây chằng chéo sau (Posterior Cruciate Ligament - PCL tear)
- Tổn thương dây chằng bên trong (Medial Collateral Ligament - MCL injuries)
- Phân độ tổn thương dây chằng bên trong (Medial collateral ligament injury grading)
- Tổn thương dây chằng bên ngoài (Lateral collateral ligament injury of the knee)
- Tổn thương góc sau ngoài ở khớp gối (Posterolateral corner injury of the knee)
- Tổn thương góc sau trong (Posteromedial corner injury of the knee)
- Tổn thương dây chằng bánh chè-đùi trong (Medial patellofemoral ligament injury)
- Đứt gân tứ đầu đùi (Quadriceps tendon rupture)
- Hội chứng dải chậu chày (Iliotibial band syndrome)
-
Tổn thương sụn chêm
- Rách ngang sụn chêm (Horizontal meniscal tear)
- Rách xuyên tâm sụn chêm (Radial meniscal tear)
- Rách dọc sụn chêm (Vertical meniscal tear)
- Rách sụn chêm kiểu quai xô (Bucket-handle meniscal tear)
- Rách sụn chêm kiểu vạt (Flap tear)
- Rách sụn chêm kiểu mỏ vẹt (Parrot beak meniscal tear)
- Rách rễ sụn chêm (Meniscal root tear)
- Rách sụn chêm phức tạp (Complex meniscal tear)
- Tách sụn chêm-bao khớp/ Tổn thương Ramp (Ramp lesion)
- Bong sụn chêm (Floating meniscus)
- Cốt hóa sụn chêm (Meniscal ossicle)
- Thoát vị sụn chêm (Meniscal extrusion)
- Nếp gấp sụn chêm (Meniscal flounces)
-
Tổn thương dạng nang ở khớp gối
- Nang Baker (Baker cyst)/Nang khoeo (Popliteal cyst).
- Nang hoạt dịch dây chằng chéo trước (Anterior cruciate ligament ganglion cyst)
- Nang hoạt dịch túi mỡ Hoffa (Hoffa fat pad ganglion cyst)
- Nang sụn chêm (Meniscal cyst)
- Viêm bao hoạt dịch dưới bánh chè nông (Superficial infrapatellar bursitis)
- Viêm bao hoạt dịch dưới bánh chè sâu (Deep infrapatellar bursitis)
- Viêm bao hoạt dịch trước bánh chè (Prepatellar bursitis)
- Viêm bao hoạt dịch gân chân ngỗng (Pes anserinus bursitis)
- Phình động mạch khoeo (Popliteal artery aneurysm)
-
Tổn thương mỡ và nếp gấp khớp gối
- Hội chứng chèn ép túi mỡ Hoffa (Hoffa fat pad impingement syndrome)
- Hội chứng chèn ép túi mỡ trên bánh chè (Anterior suprapatellar fat pad impingement syndrome)
- Hội chứng chèn ép túi mỡ trước đùi (Prefemoral fat pad impingement syndrome)
- Thoát vị túi mỡ Hoffa (Hoffa fat pad herniation)
- Hội chứng nếp gấp màng hoạt dịch phía trong khớp gối (Medial patellar plica syndrome)
-
-
Cổ chân và bàn chân
-
Tổn thương xương- khớp cổ chân
- Gãy Pilon (gãy trần xương chày)
- Gãy mắt cá sau (Posterior malleolus fracture)
- Gãy Tillaux-Chaput (gãy bong đầu dưới xương chày)
- Gãy ba mắt cá chân (Trimalleolar fracture)
- Gãy ba mặt phẳng đầu dưới xương chày (Triplane fracture)
- Phân loại Weber gãy đầu dưới xương mác (Weber classification of ankle fractures)
-
Tổn thương xương- khớp bàn chân
- Gãy cổ xương sên (Talar neck fracture)
- Gãy mỏm bên xương sên (Lateral talar process fracture)
- Gãy mỏm sau xương sên (Posterior talar process fracture)
- Gãy xương gót (Calcaneal fracture)
- Gãy bong lồi củ xương gót (Calcaneal tuberosity avulsion fracture)
- Gãy mỏm trước xương gót (Anterior calcaneal process fracture)
- Gãy xương ghe (Navicular fracture)
- Gãy xương hộp (Cuboid fractures)
- Gãy-trật Lisfranc (Gãy trật bàn chân)
- Gãy Jones (Gãy đầu gần xương bàn chân số 5)
- Gãy bong lồi củ xương bàn chân số 5 (pseudo-Jones fracture)
- Gãy do mỏi ở xương bàn chân số 5 (Stress fracture of the 5th metatarsal)
- Gãy xương do mỏi ngón 2 (March fracture)
- Xương phụ ở bàn chân (Accessory ossicles of the foot)
- Gãy xương vừng ngón cái (Hallux sesamoid fracture)
- Nhồi máu Freiberg (hoại tử xương bàn chân)
-
Tổn thương khớp chày- sên
- Tổn thương dây chằng sên-mác trước (Anterior Talofibular Ligament - ATFL injury)
- Tổn thương dây chằng sên-mác sau (Posterior Talofibular Ligament - PTFL injuries)
- Tổn thương dây chằng delta cổ chân (Deltoid ligament injuries)
- Tổn thương phức hợp dây chằng gót-ghe gan chân (Spring ligament complex injury)
-
Tổn thương gót chân và gân Achilles
- Viêm gân Achilles (Achilles tendinopathy)
- Đứt gân Achilles (Achilles tendon tear)
- Cốt hóa gân Achilles (Achilles tendon ossification)
- Viêm cạnh gân Achilles (Paratendinopathy)
- Viêm bao hoạt dịch sau gót (Retrocalcaneal bursitis)
- Hội chứng Haglund (gai xương gót)
- Hội chứng đệm mỡ gót chân (Heel fat pad syndrome)
-
Hội chứng chèn ép khớp cổ chân
- Hội chứng chèn ép trước ngoài cổ chân (Anterolateral ankle impingement)
- Hội chứng chèn ép trước cổ chân (Anterior Ankle Impingement - AAI)
- Hội chứng chèn ép sau cổ chân (Posterior ankle impingement syndrome)
- Hội chứng chèn ép sau ngoài bàn chân ngoài khớp (Extra-articular lateral hindfoot impingement syndrome)
-
-
Viêm khớp
-
Bệnh lý thoái hóa
- Thoái hóa khớp (Osteoarthritis)
- Thoái hóa khớp bàn tay (Osteoarthritis of the hand)
- Thoái hóa khớp bàn tay dạng ăn mòn (Erosive osteoarthritis)
- Thoái hóa khớp gối (Osteoarthritis of the knee)
- Thoái hóa khớp háng (Hip Osteoarthritis - Hip OA)
- Thoái hóa khớp háng tiến triển nhanh (Rapidly destructive osteoarthritis of the hip)
- Thoái hóa khớp thái dương-hàm (Osteoarthritis of the temporomandibular joint - TMJ OA)
- Thoái hóa khớp thuyền-thang-cả (Scaphotrapeziotrapezoidal - STT joint arthritis)
- Bệnh khớp thần kinh (Neuropathic joint)/ Bệnh khớp Charcot (Charcot joint)
- Bệnh khớp do Hemophilia (Hemophilic arthropathy)
- Thoái hóa khớp sau chấn thương (Post-traumatic Osteoarthritis - PTOA)
-
Bệnh lý viêm nhiễm
- Viêm khớp dạng thấp (Rheumatoid arthritis [musculoskeletal manifestations])
- Viêm khớp tự phát thiếu niên (Juvenile idiopathic arthritis - JIA)
- Viêm cột sống dính khớp (Ankylosing spondylitis)
- Viêm khớp vảy nến (Psoriatic arthritis - PsA)
- Viêm khớp phản ứng (Reactive arthritis)
- Viêm khớp liên quan đến bệnh ruột (Enteropathic arthritis - EA)
- Viêm đa khớp mô bào lưới (Multicentric Reticulohistiocytosis - MRH)
- Viêm khớp nhiễm trùng (Septic arthritis)
-
Bệnh lý lắng đọng
- Bệnh Gout
- Bệnh lắng đọng Calci Pyrophosphate Dihydrate (CPPD)/Giả Gout (Pseudogout)
- Bệnh lắng đọng Calci Apatite (Hydroxyapatite deposition disease)/Bệnh lý vai Milwaukee (Milwaukee shoulder)
- Bệnh khớp do ứ đọng sắt (Hemochromatosis arthropathy)
- Bệnh khớp do Ochronosis (Alkapton niệu)
- Tổn thương cơ xương khớp của bệnh Sarcoidosis
- Bệnh khớp do Amyloid (Amyloid arthropathy)
-
Bệnh mô liên kết
- Biểu hiện cơ xương khớp ở bệnh nhân bị Lupus ban đỏ
- Bệnh khớp Jaccoud (Jaccoud arthropathy)
- Biểu hiện cơ xương khớp của bệnh xơ cứng bì (Scleroderma)
- Tăng sản xương lan tỏa vô căn (Diffuse Idiopathic Skeletal Hyperostosis - DISH)
- Cốt hóa dây chằng dọc sau (Ossification of the Posterior Longitudinal Ligament - OPLL)
- U tế bào khổng lồ bao gân thể lan tỏa (Diffuse tenosynovial giant cell tumor)
- U sụn màng hoạt dịch nguyên phát (Primary synovial chondromatosis)
-
-
U xương
-
U từ mô xương
- Tổng quan u xương (Bone tumors)
- U xương (Osteoma)
- U xương dạng xương (Osteoid osteoma)
- U nguyên bào xương (Osteoblastoma)
- Sarcoma xương (Osteosarcoma)
- Sarcoma xương giãn mạch (Telangiectatic osteosarcoma - TOS/TAEOS)
- Sarcoma xương cạnh vỏ (Parosteal osteosarcoma)
- Sarcoma xương cạnh màng xương (Periosteal osteosarcoma)
- Bệnh Paget ở xương (Paget disease)
- Sarcoma xương thứ phát (Secondary osteosarcoma)
-
U từ mô sụn
- U sụn (Enchondroma)
- Bệnh đa u sụn (Enchondromatosis)/Bệnh Ollier
- Hội chứng Maffucci (Maffucci syndrome)(nhiều u sụn)
- Bệnh đa chồi xương di truyền (Hereditary multiple exostoses - HME)
- U xương sụn (Osteochondroma)
- U nguyên bào sụn (Chondroblastoma)
- U xơ sụn nhầy (Chondromyxoid fibroma - CMF)
- U sụn cạnh vỏ (Juxtacortical chondroma)
- Sarcoma sụn (Chondrosarcoma)
- Sarcoma sụn cạnh màng xương (Periosteal chondrosarcoma)
- Sarcoma sụn biệt hóa kém (Dedifferentiated Chondrosarcoma - DCS)
- Sarcoma sụn tế bào sáng (Clear cell chondrosarcoma)
- Chồi xương dưới móng (Subungual exostosis)
-
U từ tủy xương
- Biểu hiện ở xương của Bệnh mô bào Langerhans (Langerhans cell histiocytosis - skeletal manifestations)
- Đa u tủy (Multiple Myeloma - MM)
- Sarcoma Ewing (Ewing sarcoma)
- U lymphoma nguyên phát tại xương (Primary Bone Lymphoma - PBL)
- Di căn xương (Bone metastases)
- U tương bào đơn độc tại xương (Solitary bone plasmacytoma)
-
Các u và giả u khác
- Nang xương đơn giản (Simple Bone Cyst - SBC)
- Nang xương phình mạch (Aneurysmal Bone Cyst - ABC)
- U giả do Hemophilia (Hemophilic pseudotumor)
- U tế bào khổng lồ của xương (Giant Cell Tumor - GCT of bone)
- U máu ở xương (Primary intraosseous hemangioma)
- U men răng (Ameloblastoma)
- U mỡ trong xương (Intraosseous lipoma)
- Đảo xương (Bone island)
- U dây sống ác tính (Sarcoma Chordoma)
-
-
U mô mềm
-
U nguyên bào sợi/U nguyên bào cơ
- U sợi ác tính (Malignant Fibrous Histiocytoma - MFH)/ Sarcoma đa hình thái không biệt hóa (Undifferentiated Pleomorphic Sarcoma - UPS)
- Bệnh u sợi hệ cơ xương khớp (Musculoskeletal fibromatoses)
- Viêm cân cơ dạng nốt (Nodular fasciitis)
- Viêm cơ cốt hóa (Myositis ossificans)
- U sợi hyaline ở trẻ vị thành niên (Juvenile hyaline fibromatosis)
- U sợi dạng desmoid/ U sợi xâm lấn tại chỗ (Desmoid-Type Fibromatosis/Aggressive fibromatosis)
- U sợi đơn độc (Solitary fibrous tumor)
- Sarcoma sợi bì lồi (Dermatofibrosarcoma Protuberans - DFSP)
- U sợi đàn hồi vùng lưng (Elastofibroma Dorsi)
-
U mạch máu
- U cuộn mạch (Glomus tumor)
- U máu (Hemagioma) mô mềm (Soft tissue hemangioma)
- Hội chứng Klippel-Trénaunay (Klippel-Trénaunay syndrome)
- U nội mô mạch máu (Hemangioendothelioma)
- U nội mô mạch máu dạng Kaposi (Kaposiform hemangioendothelioma - KHE)
- Sarcoma mạch máu ở mô mềm (Musculoskeletal angiosarcoma)
-
Loạn sản xương
-
Loạn sản ngắn chi
- Loạn sản sụn (Achondroplasia)
- Loạn sản xương gây chết (Thanatophoric Dysplasia)
- Bệnh tạo xương bất toàn/ Xương thủy tinh (Osteogenesis Imperfecta - OI)
- Loạn dưỡng lồng ngực gây ngạt (Asphyxiating thoracic dysplasia)
- Loạn sản sụn-ngoại bì (Chondroectodermal dysplasia)
- Loạn sản đốt sống-đầu xương (Spondyloepiphyseal dysplasia - SED)
- Loạn sản đa đầu xương (Multiple Epiphyseal Dysplasia - MED)
-
Loạn sản đặc xương
- Bệnh xương sáp (Melorheostosis)
- Bệnh loạn sản thân xương tiến triển (Progressive diaphyseal dysplasia)
- Bệnh xương hóa đá (Osteopetrosis)
- Bệnh xương đặc đốm (Osteopoikilosis)
- Bệnh xương hóa đá kèm tiêu các đốt ngón xa (Pyknodysostosis)
- Bệnh xương sọc (Osteopathia striata)
- Bệnh đặc xương chậu (Osteitis condensans ilii)
-
-
Bệnh lý tủy xương
-
Hoại tử vô mạch
- Hoại tử vô mạch chỏm xương cánh tay (Osteonecrosis of the humeral head)
- Hoại tử vô mạch chỏm con xương cánh tay (Osteonecrosis of the capitellum)
- hoại tử vô mạch xương thuyền (Osteonecrosis of the scaphoid bone)
- Hoại tử vô mạch xương nguyệt (Kienböck disease)
- Hoại tử vô mạch chỏm xương bàn tay (Mauclaire disease)
- Hoại tử vô mạch chỏm xương đùi (Osteonecrosis of the femoral head)
- Hoại tử vô mạch vô căn chỏm xương đùi ở trẻ em (Perthes disease/Legg-Calvé-Perthes disease)
- Hoại tử vô mạch ở gối (Osteonecrosis of the Knee)
- Hoại tử vô mạch xương ghe ở người lớn (Müller-Weiss syndrome)
- Hoại tử vô mạch xương ghe ở trẻ em (Köhler disease)
- Hoại tử vô mạch chỏm xương bàn chân (Freiberg disease)
- Hoại tử vô mạch thân đốt sống (Kümmell disease)
-
Bệnh lý cơ xương khớp ở thanh thiếu niên
-
Bất thường phát triển
- Lệch xương trụ (Ulnar variance)
- Thiểu sản ổ chảo (Glenoid hypoplasia)
- Biến dạng cổ tay Madelung (Madelung deformity)
- Loạn sản khớp háng (Developmental dysplasia of the hip)
- Trượt chỏm xương đùi (Slipped upper femoral epiphysis)
- Khiếm khuyết đầu trên xương đùi bẩm sinh (Proximal Femoral Focal Deficiency - PFFD)
- Bệnh Blount (Chân vòng kiềng)
- Bàn chân bẹt (Pes planus)
- Bàn chân vòm cao (Pes cavus)
- Dính xương cổ chân (Tarsal coalition)
-
-
Tiết niệu
-
Khoang sau phúc mạc
-
U sau phúc mạc
- Sarcoma mỡ sau phúc mạc (Retroperitoneal liposarcoma)
- U cận hạch sau phúc mạc (Extra adrenal paraganglioma)
- Sarcoma đa hình không biệt hóa sau phúc mạc (Undifferentiated Pleomorphic Sarcoma - UPS)
- Sarcoma cơ trơn sau phúc mạc (Retroperitoneal leiomyosarcoma)
- Sarcoma cơ vân sau phúc mạc (Retroperitoneum Rhabdomyosarcoma)
- U nguyên bào thần kinh (Neuroblastoma)
- U hạch thần kinh (Ganglioneuroma)
- Lymphoma sau phúc mạc (Retroperitoneal lymphoma)
-
Thận
-
Bất thường bẩm sinh
- Bất sản thận (Renal agenesis)
- Thiểu sản thận (Renal hypoplasia)
- Thận phụ (Accessory kidney)
- Thận móng ngựa (Horseshoe kidney)
- Thận hợp nhất lạc chỗ bắt chéo (Crossed fused renal ectopia)
- Thận hợp nhất lạc chỗ vùng chậu (Pancake kidney)
- Thận lạc chỗ vùng chậu (Pelvic kidney)
- Thận lạc chỗ (Ectopic kidney)
- Thận xoay bất toàn (Abnormal renal rotation)
- Thận lạc chỗ lồng ngực (Intrathoracic kidney)
- Thùy phôi thai thận (Persistent fetal lobulation of the kidneys)
- Cột Bertin phì đại (Hypertrophied column of Bertin)
- Thận bướu lạc đà (Dromedary hump)
- Động mạch thận phụ (Multiple renal arteries)
- Biến thể tĩnh mạch thận (Renal vein anomalies)
- Hệ bài tiết đôi (Duplex collecting system)
- Giãn đài thận bẩm sinh (Congenital megacalyces)
- Tắc nghẽn chỗ nối bể thận-niệu quản (Ureteropelvic junction obstruction - UPJ obstruction)
- Bể thận ngoài thận (Extrarenal pelvis)
-
Bệnh lý viêm nhiễm
- Viêm bể thận cấp (Acute pyelonephritis)
- Viêm bể thận mạn (Chronic pyelonephritis)
- Viêm bể thận u hạt vàng (Xanthogranulomatous pyelonephritis - XGP)
- Viêm bể thận sinh hơi (Emphysematous pyelitis)
- Viêm thận-bể thận sinh hơi (Emphysematous pyelonephritis)
- Thận ứ mủ (Pyonephrosis)
- Áp xe thận (Renal abscess)
- Áp xe quanh thận (Perinephric abscess)
- Lao thận (Renal tuberculosis)
-
Nang thận
- Phân loại nang thận Bosniak
- Nang thận đơn giản ( Renal simple cyst)
- Nang xoang thận (Renal sinus cyst)
- Bệnh thận đa nang di truyền trội (Autosomal Dominant Polycystic Kidney Disease - ADPKD)
- Bệnh thận đa nang di truyền lặn (Autosomal Recessive Polycystic Kidney Disease - ARPKD)
- Bệnh thận dạng nang khu trú (Localized cystic renal disease - LCRD)
- Bệnh thận đa nang mắc phải (Acquired Cystic Kidney Disease - ACKD)
- Bệnh thận do Lithium (Lithium-induced renal disease)
- Loạn sản thận đa nang (Multicystic Dysplastic Kidney - MCDK)
- Nang thận do Bệnh von Hippel-Lindau (Von Hippel-Lindau disease)
-
Khối u ác tính
- Ung thư biểu mô tế bào thận (Renal Cell Carcinoma - RCC)
- Phân loại giai đoạn Ung thư biểu mô tế bào thận (TNM)- Renal cell carcinoma (TNM staging)
- Ung thư biểu mô chuyển tiếp của bể thận (Transitional cell carcinoma of renal pelvis)
- Lymphoma thận (Renal lymphoma)
- Phân loại giai đoạn ung thư bể thận (Urothelial carcinoma of the renal pelvis (staging))
-
Bệnh lý nội khoa
- Thận ứ nước (Hydronephrosis)
- Hoại tử ống thận cấp (Acute Tubular Necrosis - ATN)
- Hoại tử vỏ thận (Renal cortical necrosis)
- Hoại tử nhú thận (Renal papillary necrosis)
- Bệnh thận mạn (Chronic Kidney Disease - CKD)
- Mỡ hóa nhu mô thận (Renal Replacement Lipomatosis)
- Bệnh tích tụ mỡ xoang thận (Renal sinus lipomatosis)
-
Bệnh lý mạch máu
- Hẹp động mạch thận (Renal artery stenosis - RAS)
- Huyết khối tĩnh mạch thận (Renal vein thrombosis)
- Tắc động mạch thận (Renal artery occlusion)
- Nhồi máu thận (Renal infarction)
- Dị dạng động-tĩnh mạch thận (Renal Arteriovenous Malformation - AVM)
- Rò động-tĩnh mạch thận (Renal Arteriovenous Fistula - AVF)
-
-
Bàng quang
-
Khối u bàng quang
- U cơ trơn bàng quang (Leiomyoma of the urinary bladder)
- Ung thư biểu mô tế bào chuyển tiếp ở bàng quang (Transitional cell carcinoma (urinary bladder))
- Phân loại giai đoạn ung thư của bàng quang (Transitional cell carcinoma of the bladder (staging))
- Ung thư biểu mô tuyến của bàng quang (Adenocarcinoma urinary bladder)
-
Tiền liệt tuyến và túi tinh
-
Khối u tiền liệt tuyến
- Phì đại lành tính tuyến tiền liệt (Benign Prostatic Hyperplasia - BPH)
- Nang ống Muller (Müllerian duct cyst)
- Nang ống phóng tinh (Ejaculatory duct cyst)
- Nang túi bầu dục tuyến tiền liệt (Prostatic utricle cyst)
- Ung thư biểu mô tuyến tiền liệt (Prostate cancer)
- Sarcoma tuyến tiền liệt (Prostate sarcoma)
- Phân loại giai đoạn ung thư tuyến tiền liệt (Prostate cancer (staging))
-
-
Cột sống
-
Bẩm sinh
-
Loạn sản ống sống
- Tật loạn sản ống sống (Spinal dysraphism)
- Xoang bì bẩm sinh (Dorsal dermal sinus)
- Thoát vị màng tủy bẩm sinh (Congenital spinal meningocele)
- Thoát vị tủy mỡ màng tủy (Lipomyelomeningocele)
- Thoát vị tủy màng tủy (Myelomeningocele)
- Tủy chẻ đôi (Diastematomyelia)
- Tật nứt đốt sống (Spina bifida)
- Hội chứng tủy sống bám thấp (Tethered cord syndrome)
- U mỡ dây tận (Lipoma of the filum terminale)
-
Chấn thương cột sống
-
Gãy xương sống cổ
- Gãy đốt sống cổ (Cervical spine fractures)
- Gãy lồi cầu xương chẩm (Occipital condyle fracture)
- Trật khớp chẩm đội (Atlanto-occipital dissociation injuries)
- Gãy đốt đội C1 (Gãy Jefferson )
- Trật khớp xoay C1-C2 (Atlanto-axial rotary fixation)
- Gãy mỏm răng C2 (Odontoid fracture)
- Gãy trượt đốt sống trục C2 (Hangman fracture)
- Gãy bong mỏm gai (Gãy Clay-Shoveler)
- Gãy xương cổ hình giọt lệ do gập (Flexion teardrop fracture)
- Gãy xương cổ hình giọt lệ do ngửa (Extension teardrop fracture)
- Trật khớp liên mấu (Facet dislocation)
-
Gãy xương sống ngực- thắt lưng
- Gãy cột sống ngực - thắt lưng (Thoracolumbar spine fracture)
- Gãy trật do gập mạnh (Gãy Chance )
- Gãy mỏm ngang (Transverse process fracture)
- Khuyết eo đốt sống (Spondylolysis)
- Gãy sụn viền cung sau (Posterior ring apophyseal fracture)
- Gãy trật cột sống ngực thắt lưng (Thoracic spine fracture-dislocation)
- Gãy cuống sống do mỏi (Pedicle stress fracture)
-
Các kiểu hình gãy xương
- Gãy cột sống dạng que phấn (Chalk stick fracture)
- Gãy lún đốt sống (Spinal compression fracture)
- Gãy nát cột sống (Burst fracture)
- Gãy lún cột sống hình chêm (Spinal wedge fracture)
- Gãy dẹt đốt sống (Vertebra plana)
- Tổn thương trượt xoay cột sống (Translation-rotation spine injuries)
- Trượt đốt sống (Spondylolisthesis)
-
-
Thoái hóa cột sống
-
Thoát vị đĩa đệm
- Thoái hóa cột sống (Spondylosis)
- Cách đọc thoát vị đĩa đệm (Degenerated disc)
- Mất nước đĩa đệm (Disc dehydration)
- Rách vòng sợi (Annular fissure)
- Phình đĩa đệm (Disc bulge)
- Lồi đĩa đệm (Disc protrusion)
- Thoát vị đĩa đệm thực sự (Disc extrusion)
- Thoát vị đĩa đệm có mảnh rời (Sequestrated disc)
- Thoát vị đĩa đệm trong thân đốt sống (nốt Schmorl)
- Nang đĩa đệm (Discal cyst)
- Thay đổi mâm sống theo phân loại Modic (Modic type endplate changes)
- Thoái hóa đốt sống cổ (Cervical spondylosis)
- Thoát vị tủy sống ra trước (Ventral cord herniation)
-
-
-
Phụ Khoa
-
Tử cung
-
Bất thường bẩm sinh
- Dị dạng tử cung bẩm sinh/ Các bất thường ống Muller (Müllerian duct anomalies)
- Phân loại bất thường ống Müllerian (AFS classification of Müllerian anomalies)
- Tử cung hình cung (Arcuate uterus)
- Bất sản tử cung (Uterine agenesis)
- Hội chứng MRKH/ Bất sản ống Muller (Mayer-Rokitansky-Küster-Hauser syndrome)
- Tử cung một sừng (Unicornuate uterus)
- Tử cung đôi (Uterus didelphys)
- Tử cung hai sừng (Bicornuate uterus)
- Tử cung có vách ngăn (Septate uterus)
- Tử cung hình chữ T (T-shaped uterus)
- Hội chứng HWW/OHVIRA (Herlyn-Werner-Wunderlich syndrome)
-
Khối u nội mạc ác tính
- Carcinoma nội mạc tử cung (Endometrial carcinoma)
- U mô đệm nội mạc tử cung (Endometrial Stromal Tumors - EST)
- Carcinosarcoma tử cung (Carcinosarcoma of the uterus)
- Bệnh lý nguyên bào nuôi thai kỳ (Gestational Trophoblastic Disease - GTD)
- Phân loại giai đoạn Carcinoma nội mạc tử cung (Endometrial carcinoma staging)
-
Khối u cơ trơn lành tính
- U xơ tử cung (Uterine leiomyoma)
- Phân loại FIGO cho u xơ tử cung (FIGO classification system for uterine leiomyoma)
- Thoái hóa Hyaline của u xơ tử cung (Hyaline degeneration of a leiomyoma)
- Thoái hóa nhầy của U xơ tử cung (Myxoid degeneration of a leiomyoma)
- Thoái hóa Đỏ của u xơ tử cung (Red degeneration of a leiomyoma)
- Thoái hóa Nang của u xơ tử cung (Cystic degeneration of a leiomyoma)
- U cơ trơn tử cung lan tỏa (Diffuse uterine leiomyomatosis)
- U cơ trơn di căn lành tính (Benign metastasizing leiomyoma)
- U mỡ cơ trơn tử cung (Uterine lipoleiomyoma)
-
-
Buồng trứng
-
Nang buồng trứng
- Nang buồng trứng (Ovarian cyst)
- Gò noãn (Cumulus oophorus)
- Nang noãn buồng trứng (Ovarian follicular cyst)
- Nang hoàng thể (Corpus luteal cyst)
- Nang buồng trứng xuất huyết (Hemorrhagic ovarian cyst)
- Vỡ nang buồng trứng (Ruptured ovarian cyst)
- Nang hoàng tuyến (Theca lutein cyst)
- Nang vùi buồng trứng (Serous inclusion cysts of the ovary)
- Nang vùi phúc mạc (Peritoneal inclusion cyst)
- Hội chứng quá kích buồng trứng (Ovarian Hyperstimulation Syndrome - OHSS)
- Buồng trứng đa nang (Polycystic Ovarian Morphology - PCOM)
- Lạc nội mạc tử cung (Endometriosis)
- Nang lạc nội mạc tử cung (Endometrioma)
-
U biểu mô buồng trứng
- Tổng quan các khối u biểu mô buồng trứng (Ovarian epithelial tumors)
- Nang tuyến dịch trong buồng trứng (Ovarian serous cystadenoma)
- Ung thư nang tuyến dịch trong buồng trứng (Ovarian serous cystadenocarcinoma)
- Nang tuyến dịch nhầy (Ovarian mucinous cystadenoma)
- Ung thư nang tuyến dịch nhầy buồng trứng (Ovarian mucinous cystadenocarcinoma)
- Ung thư biểu mô dạng nội mạc tử cung của buồng trứng (Endometrioid carcinoma of the ovary)
- Ung thư biểu mô tế bào sáng của buồng trứng (Ovarian clear cell carcinoma)
- U Brenner (Brenner tumor)
- U nang sợi tuyến/ U sợi tuyến buồng trứng (Cystadenofibroma/ Adenofibroma)
-
U tế bào mầm
- Tổng quan các khối u tế bào mầm của buồng trứng (Germ cell tumors of the ovary)
- U quái trưởng thành (Mature cystic ovarian teratoma)
- U quái không trưởng thành của buồng trứng (Immature ovarian teratoma)
- U Dysgerminoma (Ovarian dysgerminoma)
- U túi noãn hoàng buồng trứng (Ovarian yolk sac tumor)
- Ung thư nguyên bào nuôi buồng trứng (Ovarian choriocarcinoma)
- U tuyến giáp buồng trứng (Struma ovarii)
-
U mô đệm- dây sinh dục
- Tổng quan các khối u mô đệm / dây sinh dục của buồng trứng (Sex cord / stromal ovarian tumors)
- U sợi buồng trứng (Ovarian fibroma)
- U vỏ buồng trứng (Ovarian thecoma)
- U sợi vỏ buồng trứng (Ovarian fibrothecoma)
- Khối u mô đệm xơ hóa (Sclerosing Stromal Tumor - SST)
- U tế bào hạt của buồng trứng (Granulosa cell tumor of the ovary)
- U tế bào Sertoli-Leydig buồng trứng (Sertoli-Leydig Cell Tumor - SLCT)
-
-
-
Đầu mặt cổ
-
Họng, Thanh quản và Viêm nhiễm Sâu
-
Bệnh lý vòm họng
- Nang Tornwaldt (Tornwaldt cyst)
- Nang ứ đọng khoang niêm mạc hầu (Retention Cyst of Pharyngeal Mucosal Space)
- Ung thư biểu mô vòm họng (Nasopharyngeal carcinomas - NPC)
- Ung thư biểu mô tế bào vảy khoang miệng (Squamous cell carcinoma (oral cavity))
- Phân loại giai đoạn Ung thư biểu mô Khoang miệng (Oral cavity carcinoma (staging))
- Phân giai đoạn Ung thư vòm họng (Nasopharyngeal cancer (staging))
-
Hạ họng- Thanh quản
- Nang thanh quản (Laryngeal cyst)
- Túi khí thanh quản (Laryngocele)
- Chấn thương thanh quản (Laryngeal trauma)
- Ung thư biểu mô tế bào vảy của thanh quản (Squamous cell carcinoma of the larynx)
- Ung thư biểu mô tế bào vảy hạ hầu (Hypopharyngeal squamous cell carcinoma)
- Ung thư biểu mô tế bào vảy vùng hầu họng (Oropharyngeal squamous cell carcinoma - OPSCC)
- Phân giai đoạn ung thư biểu mô hạ hầu (Hypopharyngeal carcinoma (staging))
- Phân giai đoạn Ung thư biểu mô Thanh quản (Laryngeal carcinoma (staging))
-
Viêm nhiễm- Áp xe sâu
- Viêm amidan (Tonsillitis)
- Áp xe amidan (Intratonsillar abscess)
- Áp xe quanh amidan (Peritonsillar abscess)
- Áp xe khoang cơ cắn (Masticator Space Abscess)
- Tụ máu sau hầu tự phát (Spontaneous retropharyngeal hemorrhage)
- Viêm gân vôi hóa trước sống (Calcific tendinitis of the longus colli muscle)
- Viêm thanh khí phế quản cấp (Croup)
- Viêm trên thanh môn (Epiglottitis)
- Áp xe dưới hàm (Submandibular abscess)
- Áp xe cạnh hầu (Parapharyngeal abscess)
- Áp xe sau hầu (Retropharyngeal abscess)
- Viêm mô tế bào sàn miệng (Ludwig's Angina)
-
-
Tuyến nước bọt
-
Viêm nhiễm
- Viêm tuyến mang tai (Parotitis)
- Bệnh Sjögren (Sjögren disease)
- Bệnh Kimura (Kimura disease)
- Tổn thương lympho tuyến mang tai lành tính (Benign Lymphoepithelial Lesion - BLL)
- Viêm tuyến nước bọt (Sialadenitis)
- Sỏi tuyến nước bọt (Sialolithiasis)
- Chấn thương tuyến nước bọt (Salivary gland trauma)
- Giãn ống tuyến nước bọt (Sialectasis)
-
Khối u lành tính
- U tuyến nước bọt đa hình (Pleomorphic adenoma of the salivary glands)
- U máu tuyến mang tai ở trẻ sơ sinh (Parotid infantile hemangioma)
- U Warthin (Warthin tumor)
- Nang nước bọt (Sialocele)
- U mỡ tuyến mang tai (Parotid lipoma)
- Nang nhái (Ranula)
- Oncocytoma tuyến nước bọt (Oncocytoma of the salivary glands)
-
Khối u ác tính
- Ung thư biểu mô nhầy bì tuyến nước bọt (Mucoepidermoid carcinoma of salivary glands)
- Ung thư biểu mô tuyến dạng nang của tuyến nước bọt (Adenoid cystic carcinoma of the salivary gland)
- Ung thư biểu mô tế bào nang tuyến nước bọt (Acinic cell carcinoma of salivary glands)
- Ung thư biểu mô xuất phát từ u tuyến đa hình (Carcinoma ex pleomorphic adenoma - Ca-ex-PA)
- Lymphoma không Hodgkin ở tuyến mang tai (Parotid Non-Hodgkin Lymphoma)
- Ung thư biểu mô ống tuyến nước bọt (Salivary duct carcinomas - SDC)
-
-
Hạch, mạch máu, thần kinh Cổ
-
Bệnh lý mạch máu
- Động mạch cảnh hôn nhau (Kissing carotids)
- Bóc tách động mạch cảnh trong (Internal carotid artery dissection)
- Giả phình động mạch cảnh (Carotid artery pseudoaneurysm)
- Hội chứng đau động mạch cảnh (Carotidynia)
- Huyết khối tĩnh mạch cảnh (Jugular Vein Thrombosis - JVT)
- Bóc tách động mạch đốt sống (Vertebral artery dissection)
-
U nguyên phát thần kinh
- Schwannoma dây thần kinh hàm dưới (Masticator Space CNV3 Schwannoma)
- U thể cảnh/ u cận hạch thể cảnh (Carotid Body Paraganglioma)
- U cận hạch dây thần kinh lang thang (Vagal paraganglioma)
- Schwannoma dây thần kinh lang thang (Vagal schwannoma)
- Schwannoma chuỗi giao cảm (Sympathetic Chain Schwannoma - SCSC)
- Schwannoma đám rối cánh tay (Brachial Plexus Schwannoma)
-
-
Mũi, Xoang
-
Viêm nhiễm
- Viêm mũi xoang cấp (Acute rhinosinusitis)
- Viêm mũi xoang mạn (Chronic rhinosinusitis - CRS)
- Biến chứng của viêm mũi xoang (Complications of Rhinosinusitis)
- U phồng Pott (Pott puffy tumor- Biến chứng viêm mũi xoang)
- Viêm mũi xoang dị ứng do nấm (Allergic Fungal Rhinosinusitis - AFRS)
- U nấm xoang (Paranasal sinuses mycetomas)
- Viêm xoang do nấm xâm lấn cấp tính (Acute invasive fungal sinusitis - AIFS)
- Ứ nhầy xoang (Paranasal sinus mucoceles)
- Hội chứng xoang im lặng (Silent sinus syndrome - SSS)
- U hạt Wegener ở mũi (Granulomatosis with polyangiitis)
- Thủng vách ngăn mũi (Nasal septal perforation)
-
U lành
- Polyp mũi xoang (Sinonasal polyposis)
- Polyp mũi xoang cửa mũi sau (Antrochoanal polyps - ACP)
- Loạn sản sợi ở mũi xoang (Sinonasal Fibrous Dysplasia)
- U xương mũi xoang (Paranasal sinus osteomas)
- U xơ mạch vòm mũi họng ở tuổi vị thành niên (Juvenile nasopharyngeal angiofibromas - JNA)
- U nhú lộn ngược mũi xoang (Inverted papillomas)
- U máu mao mạch dạng thùy ở khoang mũi (Lobular capillary hemangioma of the nasal cavity)
- Nang ứ đọng xoang cạnh mũi (Paranasal sinus retention cysts)
-
U ác tính
- Ung thư biểu mô tế bào vảy mũi xoang (Sinonasal squamous cell carcinomas - SCC)
- Ung thư biểu mô tuyến mũi xoang (Sinonasal adenocarcinomas)
- Ung thư biểu mô không biệt hóa mũi xoang (Sinonasal undifferentiated carcinomas - SNUC)
- U nguyên bào thần kinh khứu giác (Olfactory neuroblastomas)
- Lymphoma mũi xoang (Sinonasal lymphoma)
- Melanoma niêm mạc mũi xoang (Sinonasal mucosal melanomas)
-
Hàm mặt và khớp cắn
-
U lành
- U xơ hóa xi măng xương hàm (Cemento-ossifying fibroma - COF)
- U răng (Odontoma)
- U men răng (Ameloblastomas)
- U nhầy răng (Odontogenic myxomas)
- U tuyến răng (Adenomatoid odontogenic tumors - AOT)
- Lồi xương hàm dưới (Mandibular torus)
- Lồi xương hàm trên (Maxillary torus)
- Tổn thương tế bào khổng lồ trung tâm (Central giant cell lesions granuloma)
-
Chấn thương hàm mặt
-
Gãy xương phức tạp
- Gãy xương Le Fort (Le Fort fracture classification)
- Gãy phức hợp mũi sàng ổ mắt (Naso-orbitoethmoid (NOE) complex fracture)
- Gãy hốc mắt "blow-out" (Orbital blow-out fracture)
- Gãy hốc mắt "blow-in" (Orbital blow-in fractures)
- Gãy phức hợp gò má - hàm trên (Zygomaticomaxillary complex fracture)
- Gãy xoang trán (Frontal sinus fractures)
- Gãy xương xoang cạnh mũi (Paranasal sinus fractures)
-
Mắt
-
Mạch máu và u lành
- Dị dạng tĩnh mạch thể hang ở ổ mắt (Orbital cavernous venous malformations)
- Giãn tĩnh mạch ổ mắt (Orbital venous varix)
- Dị dạng bạch mạch ổ mắt (Orbital lymphatic malformations)
- U máu mao mạch ổ mắt (Capillary hemangiomas of the orbit)
- U tế bào đệm đường thị giác (Optic pathway gliomas - OPGs)
- U màng não thần kinh thị (Optic nerve sheath meningioma)
- U tuyến đa hình của tuyến lệ (Pleomorphic adenomas of the lacrimal glands)
-
Viêm nhiễm
- Nhiễm trùng ổ mắt (Orbital infection)
- Áp xe dưới màng xương ổ mắt (Subperiosteal abscesses of the orbit - SPA)
- Viêm nội nhãn (Endophthalmitis)
- Bệnh mắt do tuyến giáp (Thyroid-associated orbitopathy - TAO)
- Viêm ổ mắt giả u (orbital pseudotumor)
- Viêm tuyến lệ (Dacryoadenitis)
- Sarcoidosis mắt - Sarcoidosis (orbital manifestations)
- Viêm dây thần kinh thị (Optic neuritis)
-
Chấn thương
- Vỡ nhãn cầu (Globe rupture)
- Dị vật nội nhãn (Ocular foreign body)
- Lệch thủy tinh thể (Ectopia lentis)
- Xuất huyết dịch kính (Vitreous hemorrhage)
- Hội chứng Terson (Terson syndrome)
- Bong võng mạc (Retinal detachment)
- Bong hắc mạc (Choroidal detachment)
- Hội chứng đỉnh hốc mắt (Orbital apex syndrome)
- Hội chứng khoang hốc mắt (Orbital compartment syndrome)
-
Sàn sọ
-
U sàn sọ
- U màng não nền sọ (Skull base meningioma)
- Thoát vị não thái dương (Temporal encephaloceles)
- Thoát vị não xương bướm (Sphenoidal encephaloceles)
- Loạn sản sợi nền sọ (Skull Base Fibrous Dysplasia)
- Bệnh mô bào Langerhans nền sọ (Skull Base Langerhans Cell Histiocytosis - LCH)
- Đa u tủy nền sọ (Skull Base Multiple Myeloma - MM)
- Di căn nền sọ (Skull Base Metastasis)
- Chondrosarcoma nền sọ (Chondrosarcoma of the skull base)
- Viêm tủy xương nền sọ (Skull base osteomyelitis - SBO)
-
Xương thái dương
-
Lỗ tai ngoài
- Lỗ nhĩ (Foramen tympanicum)
- Tịt ống tai ngoài (External auditory canal atresia)
- Chồi xương ống tai ngoài (External auditory canal exostoses)
- Viêm hoại tử tai ngoài (Necrotizing otitis externa - NOE)
- Nút sừng ống tai ngoài (Keratosis obturans)
- Xơ hóa ống tai ngoài đoạn trong (Medial canal fibrosis)
- U xương ống tai ngoài (External auditory canal osteomas)
- Ung thư biểu mô tế bào vảy ống tai ngoài (External Auditory Canal Squamous Cell Carcinoma - EAC SCCa)
- Cholesteatoma ống tai ngoài (External auditory canal cholesteatomas - EACC)
-
Tai giữa- Xương chũm
- Tịt cửa sổ bầu dục (Oval window atresia)
- Động mạch cảnh trong lệch ra ngoài (Lateralized internal carotid artery)
- Động mạch cảnh trong lạc chỗ (Aberrant internal carotid artery)
- Tồn tại động mạch bàn đạp (Persistent stapedial artery - PSA)
- Viêm xương chũm cấp (Acute mastoiditis)
- Viêm tai-xương chũm mạn tính (Chronic otomastoiditis)
- Cholesteatoma mắc phải (Acquired cholesteatomas)
- U cuộn nhĩ (Tympanic paragangliomas)
- Dị dạng mạch máu tĩnh mạch của thần kinh mặt (Venous vascular malformations of the facial nerve)
-
Tai trong
- Bất sản mê nhĩ hoàn toàn (Michel aplasia)
- Bất sản ốc tai (Cochlear aplasia)
- Thiểu sản ốc tai (Cochlear hypoplasia)
- Phân chia không hoàn toàn ốc tai loại I (Cochlear incomplete partition type I)
- Phân chia không hoàn toàn ốc tai loại II (Cochlear incomplete partition type II)
- Phân chia không hoàn toàn ốc tai loại III (Cochlear incomplete partition type III)
- Cống tiền đình lớn (Enlarged vestibular aqueduct - EVA)
- Loạn sản ống bán khuyên (Semicircular canal dysplasia)
- Viêm mê nhĩ (Labyrinthitis)
- Viêm mê nhĩ cốt hóa (Labyrinthitis ossificans)
- U túi nội bạch huyết (Endolymphatic sac tumors - ELST)
- Schwannoma trong mê nhĩ (Intralabyrinthine schwannomas)
- Xốp xơ tai (Otospongiosis)
- Hội chứng hở ống bán khuyên trên (Superior semicircular canal dehiscence syndrome - SSCDS)
-
-
Tuyến vú
-
Kỹ thuật hình ảnh
-
Các hình ảnh học
- Nhũ ảnh (Mammography)
- Vị trí khuất trên nhũ ảnh (Forbidden areas in mammography)
- Tư thế chụp nhũ ảnh (Mammography views)
- Nhũ ảnh 3D (Digital breast tomosynthesis - DBT)
- Đặc điểm hình ảnh siêu âm tuyến vú (Benign and malignant characteristics of breast lesions at ultrasound)
- MRI vú (Breast MRI)
- X-quang ống tuyến vú cản quang (Breast ductography)
-
-
BI-RADS
-
Phân loại Bi-RADS
- Phân loại BI-RADS (Breast Imaging Reporting and Data System- BI-RADS)
- BI-RADS 1 (Breast imaging-reporting and data system (BI-RADS) assessment category 1)
- BI-RADS 2 (Breast imaging-reporting and data system (BI-RADS) assessment category 2)
- BI-RADS 3 (Breast imaging-reporting and data system (BI-RADS) assessment category 3)
- BI-RADS 4 (Breast imaging-reporting and data system (BI-RADS) assessment category 4)
- BI-RADS 5 (Breast imaging-reporting and data system (BI-RADS) assessment category 5)
-
-
Vôi hóa
-
Vôi hóa lành tính
- Vôi hóa da ở vú (Skin calcifications in the breast)
- Vôi hóa mạch máu ở vú (Vascular calcification in breast)
- Vôi hóa dạng bắp rang (Popcorn-like calcification of the breast)
- Vôi hóa dạng tiết dịch (secretory calcifications)
- Vôi hóa dạng tròn (Round breast calcifications)
- Vôi hóa dạng vỏ trứng (Eggshell calcification (breast))
- Vôi hóa loạn dưỡng (Dystrophic calcification within the breast)
- Vôi hóa chỉ khâu (Suture calcification in breast)
-
Tổn thương lành tính
-
U lành tính
- Bệnh tuyến của tuyến vú (Adenosis of the breast)
- U nhú trong ống tuyến vú (Intraductal papilloma of breast)
- U nhú thiếu niên của tuyến vú (Juvenile papillomatosis of the breast)
- Nang vú đơn thuần (Simple breast cyst)
- Nang bã nhờn tuyến vú (Breast sebaceous cyst)
- Nang phức hợp ở vú (Complex cystic and solid breast mass)
- U mô thừa tuyến vú (Breast hamartomas) (hình ảnh vú trong vú)
- U mỡ tuyến vú (Breast lipoma)
- Hoại tử mỡ tuyến vú (Fat necrosis (breast))
- U sợi tuyến vú (Fibroadenoma)
- U tế bào hạt tuyến vú (Granular cell tumor of the breast)
- U xơ cứng tuyến vú (Fibromatosis of the breast)
- Nang dầu tuyến vú (Oil cyst (breast))
- U diệp thể (Phyllodes tumors)
- Sẹo sau phẫu thuật vú (Post surgical breast scar)
- U tuyến của vú (Adenomatous breast lesions)
-
-
Tổn thương ác tính
-
U ác tính
- U tân sinh của vú (Breast neoplasms)
- Ung thư biểu mô ống tuyến tại chỗ (Ductal carcinoma in situ)
- Ung thư biểu mô tuyến vú xâm nhập loại không đặc biệt (Invasive breast carcinoma of no special type)
- Ung thư biểu mô tiểu thùy vú (Lobular breast carcinoma)
- Ung thư biểu mô tiểu thùy xâm nhập của tuyến vú (Invasive lobular carcinoma of the breast)
- U lympho của vú (Breast lymphoma)
- Ung thư biểu mô tuyến vú dạng viêm (Inflammatory carcinoma of the breast)
- U diệp thể ác tính của vú (Malignant phyllodes tumor)
- Ung thư biểu mô tuyến vú dị sản (Metaplastic breast carcinoma - MBC)
- Di căn đến vú (Metastases to the breast)
- Phân loại giai đoạn Ung thư vú (Breast cancer (staging))
-
-
-
Bài giảng
-
Lồng ngực
-
Phần 2: Mô hình và cơ chế tổn thương phổi
- Các kiểu hình bệnh lý phổi
- Xẹp phổi
- Bệnh lý khoang màng phổi, lồng ngực và cơ hoành (Pleura, Chest Wall & Diaphragm)
- Bệnh lý nhiễm trùng phổi (Pulmonary infections)
- U phổi và nốt đơn độc (lung tumors & solitary pulmonary nodule)
- Bệnh phổi mô kẽ lan tỏa (ILD)
- Bệnh lý mạch máu phổi
- Bệnh lý đường thở và trung thất (airways & mediastinum)
- Chấn thương ngực và tổn thương phổi cấp (thoracic trauma & acute lung injury)
- Hình ảnh ICU và thiết bị hỗ trợ (ICU imaging & support devices)
-
Thần kinh
-
Thần kinh
- Nền tảng thần kinh học (Neuroimaging fundamentals)
- Giải phẫu mạch máu thần kinh (Neurovascular)
- Đột quỵ (Stroke)
- Xuất huyết não & dị dạng mạch máu (Intracranial hemorrhage & vascular malformations)
- Bệnh lý tĩnh mạch não (Cerebral venous disease)
- Xuất huyết nhu mô não (Intraparenchymal hemorrhage)
- Chấn thương sọ não (Traumatic brain)
- Bệnh lý chất trắng (White matter disease)
- Bệnh lý chuyển hóa và ngộ độc não (Toxic / metabolic disorders)
- Nhiễm trùng não (Brain infection)
-
-
Đầu mặt cổ
-
Đầu mặt cổ
- Xoang cạnh mũi, hốc mũi & nền sọ trước (Sinonasal & anterior skull base)
- Mắt (Orbit)
- Gãy xương mặt (Facial fracture)
- Tuyến nước bọt (Salivary glands)
- Hố yên và nền sọ giữa (Sellar & parasellar)
- Xương thái dương & nền sọ bên (Temporal bone & lateral skull base)
- Họng (Pharynx)
- Khoang miệng & thanh quản (Oral cavity & larynx)
- Các khoang cổ sâu (Deep neck spaces)
- Hạch cổ & nhiễm trùng cổ sâu (Cervical lymph nodes & infections)
- Tuyến giáp và cận giáp (Thyroid & parathyroid)
-
-
Cột sống
-
Cột sống
- Bệnh lý trong tủy (Intramedullary lesions)
- Bệnh lý trong màng cứng - ngoài tủy (Intradural extramedullary)
- Bệnh lý ngoài màng cứng (Extradural spine)
- Thoái hóa cột sống (Degenerative spine)
- Nhiễm trùng cột sống (Spinal Infection)
- Bệnh lý cấu trúc cột sống (Hủy eo, Trượt, OPLL)
- Chấn thương cột sống (Spine trauma)
- Cột sống sau phẫu thuật (Postoperative spine)
-
-
Cơ xương khớp
-
Cơ xương khớp
- Viêm khớp (Arthritis)
- Tiếp cận u xương (Approach to bone tumors)
- Các loại u xương (Bone tumors)
- U mô mềm (Soft tissue tumors)
- Nhiễm trùng cơ xương khớp (Musculoskeletal Infection)
- Bệnh lý chuyển hóa & Huyết học xương (Metabolic & Hematologic Bone Disease)
- Đại cương gãy xương (Skeletal Trauma)
- Đại cương MRI cơ xương khớp (MRI MSK Fundamentals)
- Bàn chân & Cổ chân (Foot & Ankle)
- Khớp gối (Knee)
- Khớp háng & Khung chậu (Hip & Pelvis)
- Khớp Vai (Shoulder)
- Khuỷu tay và cẳng tay (Elbow & Forearm )
- Cổ tay & Bàn tay (Wrist & Hand)
-
-
Mạch máu
-
Mạch máu
- Giải phẫu và biến thể quai Động Mạch Chủ
- Hội chứng Động Mạch Chủ Cấp (Acute Aortic Syndrome)
- Chấn thương Động Mạch Chủ (Traumatic Aortic Injury)
- Động mạch chủ & mạch máu ngực (Thoracic Aorta)
- Động Mạch Chủ Bụng (Abdominal Aorta)
- Mạch máu tạng & chậu (Mesenteric and pelvic vessels)
- Mạch máu Chi Trên (Upper Extremity Vascular)
- Mạch máu chi dưới (lower extremity vascular)
-
-
-
Dùng thử
-
Dùng thử
-
Dùng thử
- Các mặt cắt siêu âm dị tật thai quý I
- Siêu âm thần kinh thai quý I
- Mặt và cổ thai quý I
- Các chỉ số của khuôn mặt
- Kênh nhĩ thất (AVSD)
- Shunt tĩnh mạch rốn- chủ (Bất sản ống tĩnh mạch)
- Shunt tĩnh mạch rốn- cửa- chủ (Bất thường hoặc bất sản ống tĩnh mạch DV)
- Đường dò (Sinus Tracts)
- Hội chứng Cowden (Cowden syndrome)
- Loạn sản Greenberg (Greenberg Dysplasia)
- Bài tiết thay thế (Vicarious Excretion)
- Hội chứng HELLP (HELLP Syndrome)
- Bệnh u mỡ não-xương sọ-da (Encephalocraniocutaneous lipomatosis)
-
-